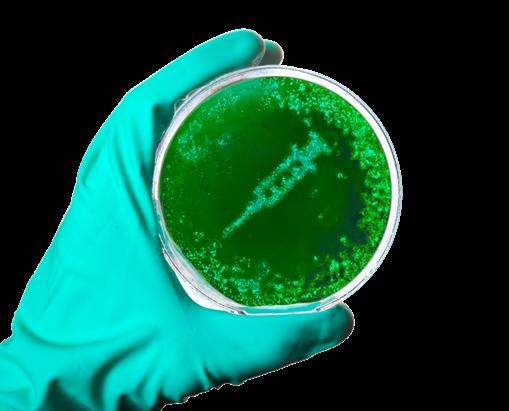

during final weeks of the flowering stage
SHOWN TO INCREASE
potency and color fade


and microelements for finish









SCAN HERE to learn more about Fade



















































































SAMSUNG EVO 437 nm



LM301H 450 nm




OSRAM 660 nm HYPER-RED













Ilove experimenting in the garden. The majority of my mad science projects happen in the basement. Outdoors, I play around with different soil amenders, compost teas, and the occasional ferment. But mostly, I let nature do her thing and hope for good weather. Indoors, where the weather is always perfect, I get a little more adventurous. My indoor gardens have almost always been fed mineral-based nutrients, and I have tried them all. Some brands have fewer products or work cleaner in my systems, but all work well with an experienced grower.
One indoor growing technique that has always eluded me was organic regenerative. I tried three or four times unsuccessfully and eventually returned to what I know works. But this spring, I attended the Growup Conference in Alberta, Canada, where I had the chance to meet Leighton Morrison and sisters Lindsay and Sarah Dawson. In different ways, they have been very successful growing organically indoors. The Dawsons haven’t changed the soil in their garden beds for six years! I was so inspired that I ran out and built horizontal beds under the guidance of Av Singh. The beds are filled with rocks, sand, silt, clay, and organic matter, all sourced from the Laurentians where I live. You can read all about it in the article “Downstairs At Eric’s - A Regenerative Reno.” It’s been two months since planting, and so far, so good!
This edition has two articles from industry champion Everest Fernandez. Rockwool is super popular with commercial growers but has had a falling off with hobbyists. Find out what makes this substrate stand out in ”Rockwool—Substrate Super Omnes!” and why you should probably give it a try (again). In the article “Nutrient Lockout in Hydroponics - Less Mulder, More Scully,” Everest helps us understand why it happens and how to avoid it.

As we continue to explore all that is mushrooms, Philip McIntosh covers “What’s In A Spore Syringe?” and “Mushroom Mating Types.”
As always, this issue of Garden Culture contains valuable and interesting information, and becoming a better grower is directly linked to what you know. Never stop learning.

Eric 3
SPECIAL THANKS TO:
Adam Clarke, Alan Creedon, Anne Gibson, Av Singh, Catherine Sherriffs, Cosmic Knot, Evan Folds, Everest Fernandez, Jennifer Cole, Marci Babineau, Philip McIntosh, Rich Hamilton, and Xavi Kief.

PRESIDENT
Eric Coulombe eric@gardenculturemagazine.com
+1-514-233-1539
EXECUTIVE EDITOR
Celia Sayers celia@gardenculturemagazine.com
+1-514-754-1539
EDITOR
Catherine Sherriffs cat@gardenculturemagazine.com
DESIGN

Job Hugenholtz job@gardenculturemagazine.com
DIGITAL & SOCIAL MARKETING social@gardenculturemagazine.com
ADVERTISING ads@gardenculturemagazine.com
PUBLISHER
325 Media INC
44 Hyde Rd., Mille-Isles QC, Canada J0R 1A0 GardenCultureMagazine.com
ISSN 2562-3540 (Print)




ISSN 2562-3559 (Online)
Garden Culture is published six times a year, both in print and online.
@GardenCulture @GardenCulture
@GardenCultureMagazine
@Garden_Culture
DISTRIBUTION
PARTNERS
• Creation Wholesale


Rich Hamilton regularly fills our pages with excellent how-to advice. An avid indoor gardener, he knows a lot about various growing methods, pest and disease control, and many other things that make our plants tick! So if you want to avoid gardening mistakes, read Rich’s articles; you’ll be a better grower.
Do you have any fun new projects on the go?
I’ve just released a new product in the UK market, which is doing well. Plant Detonator is a metabolic mobiliser that helps plants regulate their vascular system. It’s a great stand-alone product with all other plant-feed nutrients. We just got picked up by TnD distribution, Highlight Horticulture, and Creation wholesale, so I’m looking forward to the next year.

What is the most exciting thing about the gardening world right now?
PLANT DETONATOR! Joking. AI is coming, whether people like it or not, and it will revolutionise how we live, work, play, and grow. I am excited to see how we will implement it into the growing process for hobby and commercial growers.
What is your favourite way to grow plants?
I’m an indoor grower who now grows in soil and coco substrates. However, I’m well known for being a bubblers specialist. Of the three, coco gives me the most control, so when I’m growing side by side or testing genetics, I like to use a substrate that is as close to a blank canvas as possible.
What has been your biggest growing disaster ever?
When Aeroponics systems hit the UK, I tested one, got huge results, and then decided to convert my entire operation. At the time, they were expensive, so I tried to cut a few corners and bought cheap
pumps. These new systems meant we could be away from the gardens for a few days. Disaster! They worked fine for a few weeks; then, they failed while I was away from the gardens. When I returned, everything was dead. Everything! Nearly put me under. The story’s moral is that if you cut corners, you get cut short.
If you could eat only one thing for the rest of your life, what would it be?
Either Japanese or Italian. But if it were one thing only, it would be chocolate. I live near the Cadbury factory in the UK for a reason.
Returning video tapes, and I’m into the Graffiti scene in the UK, so I like to meet up with the crew and go and do our thing. I do like good books as well, and sometimes I like bad ones too. I can get lost in a book very easily. 3
We’d love to hear from you! Send us an email introducing yourself with a sample of your work
I’m an indoor grower who now grows in soil and coco substrates. However, I’m well known for being a bubblers specialist.



BUDLINK® is the original and ultimate liquid silicon product growers worldwide have enjoyed since 1997. Formulated from the ground up and including other beneficial elements, BUDLINK® is effective at all growth and flowering stages and improves strength and ability to fight against bacteria and insects. It can be integrated into any regular feeding programme.

The active ingredients are embedded into the plant’s cell walls, producing plants with thicker and greener foliage. It builds strength, adds weight, and improves the plant’s natural disease resistance. BUDLINK® helps to achieve outstanding results.
Check out HY-GENnutrients.com.au for more info.




Store and preserve all your cultivars in a small space. The Athena Tissue Culture Procedure reinvigorates old genetics and cleans plant material to outgrow infections like hop latent viroid (HLV).
Culture Kit includes everything you need to learn and perform effective tissue culture anywhere you are. The portable Flow Hood and Autoclave are purpose-built to perform consistent and clean tissue culture operations. An integrated toolbox contains all the instruments and tissue culture media to make 120 Culture Vessels (refills available).

• Flow Hood provides a large workspace with a face velocity of 0.5 - 0.9 m/s

• Purpose-built autoclave with one-touch sterilising operation
• Contains pre-formulated tissue culture media mixes: Roots and Shoots
• Media formulas contain all ingredients. Just add water
• Detailed step-by-step Procedure to perform successful tissue culture

All usage instructions are conveniently integrated into the toolbox lid. Ask for it at your local store.
The new PRO GROW 780 W EVO LED offers increased output to 2000 µmol/s BPF (ePar) and 2.8 µmol/J. The addition of the new Sam sung LM301H EVO 4000K diode is at its core.
The new EVO diode shifts the previous blue peak from 450 nm to 435 nm, moving part of the spectrum from red to blue, increasing the over all white diode efficiency. This shorter wavelength plant-centric spectrum promotes higher physical and qualitative growth than normal white LEDs or combinations of blue and red LEDs. Plants grown under this plant-centric spectrum have bigger and thicker leaves and higher levels of nutrients. Adding 20% 4000K EVO diodes into the previous mix increases yields by up to 5%. The increased blue will improve suppression of microbial growth and increase terpene production.
The new PRO GROW 780 W EVO Enhanced LED gives your plants a photon pump.
Visit ProGrow.net.au

The new PRO GROW 630 W EVO LED offers increased output to 1760 µmol/s PPF and 2.8 µmol/J. The addition of the new Samsung LM301H EVO 4000K diode is at its core.
The new EVO diode shifts the previous blue peak from 450 nm to 437 nm, moving part of the spectrum from red to blue, which increases the overall white diode efficien cy. This shorter wavelength plant-centric spectrum promotes higher physical and qualitative growth than normal white LEDs or combinations of blue and red LEDs.
Plants grown under this plant-centric spectrum have bigger and thicker leaves and higher levels of nutrients. Adding 20% 4000K EVO diodes into the previous mix increases yields by up to 5%. The increased blue will improve suppression of microbial growth and increase terpene production.
Give your plants a photon pump with the new PRO GROW 630 W EVO Enhanced LED.
Check out ProGrow.net.au for more details.
HUMIBOOSTA™ uses a blend of organic acids to improve nutrient solubility, enabling maximum nutrient availability. It is also a source of additional magnesium, an essential building block for chlorophyll production during photosynthesis. Soluble calcium is another vital ingredient during the late growth stage to ensure the plant produces and retains many flowers.

Suitable for all systems and can be used through every stage of plant growth.


Give your plants the boost they deserve from start to harvest!
Visit HY-GENnutrients.com.au

For over 100 years, Chikamasa scissors have been crafted in Japan. In the beginning, all scissors were handmade.Today, more than 50 industrial robots work to ensure high-quality scissors.These blades are razor-sharp, ensuring longevity. Fluorine coated to help slow down resin build-up, Chikamasa scissors save you time with less effort on maintenance. The OG’s of post-harvest will help give your flower the perfect finish and premium bag appeal.






Athena Mix Kit makes mixing a concentrated fertiliser mix easy and accurate. Add a single pouch to the matching 1 gallon, fill with water and shake until fully dissolved. Look for Athena 10 lb Pro Line box for refill pouches.
Weighing powders can be inaccurate and lead to batches with different mineral compositions and plant deficiencies. Mixing a concentrate before measuring into a batch tank or reservoir is always better.


Contains:

• (1) 2 lb pouch Pro Core plus 1 Gal mixing jug

• (1) 2 lb pouch Pro Bloom plus 1 Gal mixing jug

• (1) 2 lb pouch Pro Grow plus 1 Gal mixing jug
Ask for it at your local store.

Our blog is where we bring you more than we can cover in our print issues; timely news, growing tips, and great ideas. Hundreds of growing articles are waiting for you.






Rockwool is special. While you’ve probably noted the inclusion of Rockwool (aka stone wool or mineral wool) on lists of soilless growing media options, a mere bullet point belies its special status. Casually including Rockwool as ‘just another option’ in the world of hydroponics fails to do justice to its special characteristics—unique traits that truly set it apart from other soilless substrates.
A good place to start is to pay humble attention to common practices in commercial agriculture. Professionals know what they’re doing, and—will you look at that— Rockwool is everywhere! From propagation plugs for starting seedlings and stem cuttings to various-sized blocks and slabs, Rockwool is the go-to soilless growing medium for professional growers—for good reasons.
Admittedly, the word “sterility” probably falls short of conjuring up much excitement or intrigue—especially if you’re a member of the “living soil” crowd. However, I’d argue that sterility is a crucial starting point for successful indoor growing. Without natural checks and balances, introduce pests at your peril. With Rockwool, thanks to the super high temperatures involved in its manufacturing process, no fungus gnat eggs or pathogens can survive to make their way into your grow room. Unfortunately, the same can’t be said for many compost-based or coco-coir potting mixes.
Plant roots want to have their cake and eat it too! For optimal health and metabolism, root hairs demand access to water and oxygen at the same time, and that can be tricky to deliver in practice—especially for container gardeners using soil-based potting mixes prone to being over-watered. Fortunately, Rockwool couldn’t be better suited to meeting this challenge of simultaneous water and oxygen supply. Even when “saturated”, the porous structure of Rockwool allows for excellent air exchange, ensuring that plant roots receive ample oxygen for healthy growth.

This is another word that typically fails to pique interest—but you should really be paying attention to this one, especially if you’re carefully mixing up hydroponic feed solutions. Rockwool’s status as an inert material means that it won’t start chemically reacting with your nutrient solution or influence the pH of the rhizosphere. Poorly buffered coco coir, on the other hand, can claw back calci-
um and replace it with excess potassium, unbalancing your nutrient solution after the first pass. If you re-circulate, this will inevitably lead to all sorts of aggravation. On the other hand, Rockwool always gives you precise control over nutrient levels and pH.
Rockwool doesn’t just come in preformed cubes, blocks, and slabs. Other formats include loose fibres (known as Rockwool flock or granulate) and “croutons”—both of which make excellent loose-fill media options for containers if you swing that way. I enjoy the convenience and homogeneity of grow blocks—my favourite being called “Hugo”—a 6” x 6” Rockwool grow block manufactured by industry leader, Grodan. You can be sure that each of your plants is enjoying the same media volume, and there are no pots to fill—or clean. You’ll also be amazed at the size and harvest a relatively small block of Rockwool can support. Like I said, it’s a super media!
From propagation plugs for starting seedlings and stem cuttings to varioussized blocks and slabs, Rockwool is the go-to soilless growing medium for professional growers— for good reasons
This versatile “super-substrate” can generate next-level results— very high yields with excellent flavours





No—I’m not talking about your attic space, although the hydrophobic variety of Rockwool is well-known for this application. Rockwool’s insulative properties are also beneficial for plant roots, especially given that many LED-powered indoor gardens run at significantly higher air temperatures. Rockwool-grown plants enjoy more stable root zone temperatures, promoting healthy root development.
For those of you who remain sceptical of Rockwool’s myriad benefits, I tentatively suggest that you have fallen victim to what I will call “Rockwool misinformation”. Let’s take a glance over the usual suspects:
• “It’s non-renewable and eco-unfriendly.” Rockwool is derived from basalt rock—one of the most ubiquitous and abundant rock types on and in our planet—and chalk, which is also extremely plentiful. Yes, lots of energy is needed to turn this rock into lava and spin it—but the result is miraculous and well worth it.
• “It’s bad for you.” Some folks confuse Rockwool with fiberglass or asbestos—which are completely different kettles of fish. While it is true that Rockwool fibres can be irritating to the skin, eyes, and even respiratory system if proper precautions are not taken, it’s easy and even pleasant to handle in practice. Some grower friends don marigolds whenever they handle dry Rockwool. It’s never bothered me.
• “It’s just for the pros.” There are some fundamental errors to avoid with Rockwool, such as not over-saturating propagation plugs and allowing larger grow blocks and slabs time to drain properly before transplanting—but these are easily avoided with care and attention.
• “It’s a pain to pre-soak.” Some brands of Rockwool still require a pre-soak in pH-adjusted water or nutrient solution for several hours (or overnight) to reduce the alkaline pH to a range that’s more suitable for hydroponics. However, modern Rockwool products—and yes, I’m thinking specifically of Grodan—no longer require pre-soaking due to advancements in buffering technologies.
While misconceptions about Rockwool may have deterred some from using it, the truth is that this versatile “super-substrate” can generate next-level results—very high yields with excellent flavours. So try it in your propagation tent first, and thank me later! 3
• Rockwool starter cubes are ideal for starting seeds or rooting stem cuttings. Soak them in pH adjusted (5.5 – 6.0) water and shake them to drain excess moisture.
• Start feeding (very lightly!) when your seedlings show their first true set of leaves or when roots appear out of the cube.
• Only transplant into a larger block when roots are prolific—bursting out everywhere!
• Don’t “stack” blocks (i.e. place a 3” block on top of a 6” block on top of a slab.) — the root crown will get too dry, and the plant may become physically unstable.
• Pre-soak blocks and slabs in the same strength nutrient solution that your plants are already used to. Let them sit and drain for 24 hours before transplanting.
• Fresh transplants won’t need irrigating for a few days, at least!
• Top feeding with drippers is the best approach to irrigation. Once established, a good approach is to follow the “precision irrigation” technique outlined by Grodan. This means keeping EC high (especially for LED grow rooms), with the first irrigation timed for about an hour after lights on. Irrigations should be short, typically around 10 – 15 seconds per event, and regular—every hour, up until an hour or two before lights out. Regular “micro-irrigations” best exploit Rockwool’s zero CEC (cation exchange capacity). While the day’s first irrigation event might not generate any run-off, you should dial in your irrigation regime so that subsequent irrigations do. Keep an eye on the EC of your run-off, and don’t let it climb more than 25% higher than your input EC.
• Use block covers to reduce salt build-up due to evaporation and algae growth on the top surface of the blocks.
• Don’t overestimate how much Rockwool you need! A Hugo 6”x6” grow block is just 3.2L but can arguably support the same size plant as a 7L container filled with coco coir, as long as it’s irrigated regularly.
• Dry-back is essential, especially during the transition, flowering, and fruiting stages—but don’t allow your grow blocks or slabs to dry out more than 50% of their saturated weight.
Rockwool-grown plants enjoy more stable root zone temperatures, promoting healthy root development

Around the world, foods once considered commonplace are endangered; saving them may depend on the home gardener.
Once upon a time, the Marshall strawberry [1] thrived in the temperate climate of the Pacific Northwest. In the mid-20th century, it accounted for 90% of strawberry production in Washington and Oregon.
Unprocessed Marshalls were good for only a few hours after ripening. The fruit was so delicate it couldn’t be shipped without processing, freezing, packing in sugar, or cooking into jams and jellies. But this was overlooked because it was said to have been the sweetest and juiciest strawberry ever grown. Wiped out by disease in the 1960s, only small pockets of this delicious fruit remain. Stronger, hardier varieties better suited to long-distance transport have replaced it.
Around the world, fruits and vegetables continue to disappear, some never to return.
Dr Lenore Newman, Canadian Research Chair of Food Security and Environment at the University of the Fraser Valley, British Columbia, says that although climate change plays a part in food extinction, the biggest challenge in the past century has been the shift from local food production to global food trade. As specific cultivars dominate globally, adapted fruits and vegetables have vanished. Those lost fruits and vegetables carry DNA that could be valuable to breeders and enhance the biodiversity of current homogenised stocks, making them more survivable.
A perfect example is the Ansault pear [2]. First bred in France in 1863, it was sweet and aromatic with a smooth, buttery texture. However, when the pear was introduced commercially in the late 19th century, its fate was already sealed. The shift from locally produced food to global imports had begun, and mass-produced pears like Bartlett, Bosc, and Anjou flooded the marketplace.
Misshapen and irregular in size, the Ansault pear tree didn’t fit into the homogenous orchard of perfectly-coiffed trees. Moreover, it required more attention than growers interested in profit and high-yielding crops could offer. Eventually, growers stopped planting the Ansault. It faded out of existence, and its DNA, which might have been able to produce similarly tasting varieties, was lost forever.
Marie Fiore, Board Chair for Slow Food Seattle, says foods are going extinct because we’ve put our eggs in one basket. Before the globalisation of food, we relied on local farms to feed a region. When a particular food was in season, such as strawberries, you enjoyed
it and preserved some for-winter months. Now, the consumer is spoiled, expecting to see strawberries, avocados, bell peppers, and tomatoes on store shelves year-round. This sense of entitlement encourages producers to breed greenhouse or field crops able to withstand long-distance travel, pushing local growers out of the market. There’s no fallback when supply chains are disrupted, or other disasters strike. When did you last see a local farm tomato in a big-name grocery store?
Slow Food International [3] is a non-profit global organisation working to prevent the disappearance of local food cultures and traditions. This group believes agricultural biodiversity and small-scale family-based food production are in danger due to the economic push for profit and climate change. The Ark of Taste [4], under the auspices of Slow Food, promotes biodiversity and draws awareness to foods at risk. Since 1996, more than 3,500 products from over 150 countries have been added to the Ark’s international catalogue.
To be included in the catalogue, the food must meet the following criteria:
• Have limited production.
• Be in danger of disappearing within one or two generations unless immediate action is taken.
• Have cultural and/or regional significance.
• Contribute to the planet’s biodiversity.
• Have once been economically viable.

Only foods that anyone can produce, share or sell are accepted by the Ark. After a particular food is nominated, the Ark’s Commission assesses it. If it qualifies, a Presidium is often assigned to help growers establish quality, authenticity, and production standards for the product while promoting local consumption.
Fiore believes when food is lost, a part of a region’s history is too, which almost happened with Canada’s Red Fife wheat.
Wiped out by disease in the 1960s, only small pockets of this delicious fruit remain










Credited with opening up the Prairie provinces, Manitoba, Saskatchewan, and Alberta to commercialise wheat production in the 19th century, Red Fife is the oldest and highest-yielding wheat to ever grow in Canada [5]. Arriving from Scotland in 1840, it set Canadian wheat standards for over 40 years (1860-1900). Its seed was used for breeding new strains of wheat resistant to fungal disease and pests, which made the original Red Fife obsolete but not forgotten. Even today, all bread wheat produced in Canada can trace its lineage back to Red Fife, making it historically and economically significant, not just as a food source, but as the livelihood of generations of farmers.
An Ark of Taste Presidium [6] was created in the early 2000s to relaunch the original Red Fife commercially. Introducing it to artisan bakeries, it became a popular choice for baking, spurring further marketability and increased production. As a result, red Fife wheat is again growing on farms across Canada.
The numbers are staggering: The UN Food and Agriculture Organisation notes that since the 1900s, 75% of crops have been lost, spiking a decline in plant variety and putting agrobiodiversity at risk [7]
According to Dr Newman, documenting food sources, such as old orchards, are critical in preserving rare cultivars and, in some cases, showing they aren’t extinct. For example, Vancouver’s Canadian Heritage Orchard at VanDusen Botanical Gardens [8] is preservation in action. An authentic 19th-century southern British Columbia domestic apple orchard contains 16 varieties of trees dating back to the 1500s. The trees were propagated from cuttings donated by John and Josephine Riley from
their 100-year-old orchard on Bowen Island, British Columbia. Among them is the Keswick Codlin apple [9] First discovered in Lancashire in 1793, this apple was ideal for cooking and eating, becoming one of Victorian England’s most popular apple varieties. Tree grafts and seeds were carried around the world. But the Keswick Codlin was challenging to store for long periods and, by the 1930s, waned in popularity, replaced by longer-lasting apple varieties.
Variety plays an essential role in the food system, perhaps more than once believed. Dr Newman believes the hobby gardener is a crucial player in ensuring rare varieties of fruits and vegetables continue to be grown. With more time to cultivate and nurture the plants, gardeners like us can help preserve yesterday’s food for tomorrow’s dinner tables. 3
1. Marshall Strawberry - Arca del Gusto - Slow Food Foundation (fondazioneslowfood.com)

2. The Celebrated Pear That’s Been Lost To History (tastingtable. com)
3. Good, Clean, Fair and Sustainable Food for All • Slow Food USA (slowfoodusa.org)
4. Ark of Taste • Slow Food USA
5. Red Fife Wheat | The Canadian Encyclopedia
6. Red Fife Wheat - Presìdi Slow Food - Slow Food Foundation (fondazioneslowfood.com)
7. Food and Agriculture Organization of the United Nations | AGROVOC (fao.org)
8. VanDusen Botanical Garden | Canadian Heritage Orchard at VanDusen Botanical Garden (vandusengarden.org)
9. Keswick Codlin apple - Slow Food in the UK (slowfood.org.uk)
BIO Jennifer Cole is a writer and garden enthusiast with a bachelor’s degree focused on history from Simon Fraser University, and a freelance writing career spanning two and half decades. Jennifer lives in Vancouver British Columbia. Her by-lines have regularly appeared in the opinion section of the Toronto Star and her portfolio includes articles in various newspapers, magazines, and websites across Canada. When not writing her own blog or visiting local garden centres, you can find her puttering, planting, and nourishing her own urban garden oasis.
the hobby gardener is a crucial player in ensuring rare varieties of fruits and vegetables continue to be grownThe Marshall strawberry
Everyone is looking for ways to save money and grow sustainably. All gardening inputs can be managed to serve you more efficiently, including your growing media. You can use most growing media multiple times. However, you must ensure the media is suitable for reusing.
For example, a build-up of nutrients, diseased plant matter, fungal spores, or soil-borne pests can render a medium unusable. Therefore, it is essential to maintain it throughout each growth cycle and prepare it properly before reuse. Here, we will look at each popular growing medium and go through what you must do to reuse it safely.



Prepare coco properly before reusing it, or crops will face many challenges, including salt toxicity. With each growth cycle, minerals and chemical compounds from plants and nutrient products


accumulate in the growing medium. Too much salt in coco will stop nutrients from reaching the crops, resulting in nutrient lock-out. A salt-based nutrient lock-out can look like a nutrient deficiency, causing leaves to discolour and wilt. Nutrient lock-out will kill a crop if untreated.


To clean coco sufficiently, break it up and physically remove any remaining roots. Next, wash it in distilled water to remove any remaining salts. Soaking the coco in an enzyme solution to remove decaying roots from the previous crop is essential. Finally, add amendments such as mycorrhizae and other beneficial microorganisms.

Everyone is looking for ways to save money and grow sustainably
When reusing coco multiple times, it loses some of its lignin structure. Therefore, replacing it entirely after two or three crop cycles is recommended. Some growers mix new coco into older coco to extend its life. However, it will still break down after a while and struggle to hold onto roots and maintain an optimal moisture level.
Once coco has been reused several times, discard it in the outdoor garden, making for a fantastic soil amendment. Used coco is suitable for outdoor flower beds and gardens or other areas where the soil has compacted. In addition, it will bring back aeration and improve water retention.
Avoid using recycled coco for seedlings or young cuttings, which are fragile; it is best to reserve reused coco for healthy, thriving plants. When planting new crops into reused coco, water profusely with calcium-rich, coir-specific nutrients and a good rooting stimulant until run-off occurs.
As with coco, excess nutrients from previous crops will be left in the soil. Flushing these out is essential so you do not burn or lock out new crops with excess salts from the last harvest. It also means you can accurately dose your crops, knowing no significant nutrients are left in the soil.
Flushing the soil with a nutrient flush will rinse excess salts and heavy elements, leaving the soil cleaner. Even if you have already washed your soil in the final stages of your growth cycle, it is advisable to do it again if you plan to reuse it.

Give the soil a rest period and allow it to dry out, preferably in the sun. Many pathogens that growers encounter originate in the soil, including powdery mildew and root rot. Without this rest period, you risk infecting new plants. Allowing the soil to dry completely will drastically reduce disease spores. Don’t worry about any dry roots and stumps, as these will break down to form compost.
To reuse soil in pots, remove as much of the old root system for an even texture. Then, add soil amendments. For example, worm castings will help improve fertility, while perlite or peat moss will increase aeration and moisture retention.
Use a mycorrhizal inoculant before planting new crops in recycled soil. The mycorrhizal fungi form a symbiotic relationship with the plant roots, allowing for better nutrient and water uptake, improving growth and stress resistance.
If you have flushed the soil correctly, there will be relatively no nutrient availability, so a good feed at planting time is recommended. This will encourage rapid growth and reduce plant stress. In addition, maintain a proper fertilising schedule to keep microorganisms and plants healthy.
While made of entirely different materials, these growing media can be recycled similarly to potting soil and coco. However, a small amount will inevitably be lost to the plant’s root system as it extends around and grips onto the small pieces. Smaller roots may also break off and remain attached to the media. These must be removed, as small bits of root matter will decay and release CO2, suffocating fledgling root systems and transferring diseases to future crops.
To prevent this, soak the growing media with an enzyme wash. Enzyme flushes are commonly used during the growth cycle to break down dead plant matter washed out of the reservoir or made available by the plant. Once the roots are broken down, give it a good rinse and let the medium dry out for a few days before reusing. Like potting soil, allowing it to rest will help keep it sterile.
Reusing growing media is a great start to becoming a more sustainable gardener. However, there are limitations! Never go this route if a precious crop was diseased. If you’re not up for preparing and using old potting soil, you can still make the most of it instead of throwing it out. Disperse it directly into the outdoor garden or wherever you need to fill holes or eroded areas. You can also try mixing it into compost piles. This way, the old media can still help make you a more sustainable grower and save money at the same time. 3
Reusing growing media is a great start to becoming a more sustainable gardener
Give your flowering plants the organic love they deserve.

5X more Organic Phosphorus than our nearest competitor.
Better solubility in nutrient solution - pre-milled to 5 micron.
Added Kelp & Fulvic for superior biological assimilation.
Assists in the establishment of Mycorrhiza. Microbe friendly.
bioguano.com.au








Slow release, organic nitrogen for ultimate control.
Organic Nitrogen source for ultimate dosing control.

Supported by background nutrition for balanced growth.
Source of Organic Carbon for improved nutrient retention.
Feeds beneficial bacteria & improves plant health.


So you want to grow a mushroom. Probably more than one. To succeed, it helps to understand the life cycle of the species you wish to grow. Many mushroom-forming fungi require the fusion of cells between individuals with different mating types before there is any chance of producing mushrooms. The fusion of two compatible mycelia allows meiosis to occur (eventually), creating genetic diversity in the resulting spores. It’s mushroom sex, but fungi do not exist as males and females; they have mating types, and there can be more than just two.



For example, the model fungi Schizophyllum commune (split gill) and Coprinopsis cinerea (an inky cap) have an estimated 23,000 and 12,000 distinct mating types, respectively. With this many different mating types, the chances are high that any two individual fungi of the same species that encounter each other in the environment will be sexually compatible and able to reproduce. Many mushrooms grown commercially and by hobbyists must undergo some form of sexual reproduction before producing fruit bodies. To understand why, let’s review a typical basidiomycete mushroom life cycle (Figure 1).
A single mushroom can release hundreds of millions of spores under ideal conditions throughout its existence. With few exceptions, fungal spores are haploid, meaning they contain a single copy of each chromosome. Most higher organisms, such as mammals, are diploid, having two copies of each chromosome in the nucleus. Any particular spore has little chance of germinating and developing into a fully-fledged fungal colony. But if a spore finds itself in the right place at the right time, it will grow to produce threadlike cells called hyphae, which comprise the mycelium or “body” of a fungus. The hyphae range out into the environment, releasing enzymes to break down organic material to be absorbed back into the mycelium as nutrients.

A mycelium derived from a single spore can produce mushrooms if the species is homothallic. However, most mushroom-forming fungi are heterothallic, meaning mating must occur between compatible individuals before fruit body formation and meiosis can happen. The classic example of a homothallic species is Agaricus bisporis, the common button mushroom. Well-known heterothallic species include:
• Pleurotus ostreatus (oyster).
• Hericium eriniceus (lion’s mane).
• Hydnum repandum (hedgehog).
• Lentinula edodes (shiitake).
• Members of the genus Psilocybe
Haploid fungal cells derived from a single spore contain one nucleus per cell and are called homo- or monokaryons (mono = single, karyon = nucleus). When compatible mycelia of a heterothallic species encounter each other, the hyphae fuse and nuclei from each mycelium migrate into the opposite mycelium forming a state unique to basidiomycetes—the dikaryon. Functionally, this is a diploid state, but it’s not technically a true diploid because even though there are two copies of each chromosome in each cell, the
chromosomes exist in separate nuclei. The nuclei migrate to the tips of the growing hyphae, where the nuclei of opposite mating types pair up and divide synchronously to maintain the dikaryotic state indefinitely. Environmental queues such as nutrient deficiency and temperature and humidity changes trigger fruit body development, nuclear fusion, the completion of meiosis, and the formation of spores on the mushroom’s gill, spine, or pore surfaces. The spores produced in this way are genetic recombinants containing genes from both nuclei that formed the dikaryon.
A distinguishing feature of a dikaryon is the clamp connection (Figure 2). A clamp connection is formed at the location on a hypha where a new cell wall will create a septum dividing the hypha into separate cells. A small hook-like protrusion forms in the reverse direction of growth, and as the two sister nuclei divide, one moves into the hook and migrates back into the cell behind. Using this mechanism, unique to basidiomycete fungi, the fungus maintains two nuclei in each advancing cell of the mycelium, one of each genotype.
Microscopic observation of hyphae to confirm clamp connections is a sure way to verify a dikaryon (although some heterothallic fungi do not produce clamp connections). With experience, a dikaryotic mycelium can be differentiated from a monokaryotic one by its colonial morphology. A dikaryon often has a much more “ropey” form with thicker, more entwined hyphae. Such a mycelium is called rhizomorphic because of its resemblance to the spreading and branched growth of fibrous plant roots. Some species are a lot more rhizomorphic than others. Monokaryons are generally a lot fluffier and fuzzier without twisted bundles of hyphae. Dikaryons tend to grow a little faster than monokaryons.
So now you know why you generally can’t grow a mushroom from a single spore. It takes two. 3

It’s mushroom sex, but fungi do not exist as males and females; they have mating types, and there can be more than just twoPhoto: Philip McIntosh Typical basidiomycete clamp connection. Stained with cotton blue in lactic acid. Figure 2: DIKARYON CLAMP CONNECTION

... we can also fix things...
Life is alive, and life makes life. The way that our social policies and human stories have become misaligned with this reality is the primary riddle and challenge of our time. We are waking up to sacrificing ourselves through synthetic systems and the limitation of our ideas. Within the natural order, only humans can adulterate and ruin living systems. We are also the only creature that can generate ideas, which means we can screw it all up, but through our consciousness and ingenuity, we can also fix things.
In college, following a strong intuition that everything is connected, my degrees were in biology and religion. However, the modern education system is not designed to teach integration; it teaches about trees, not forests. So I graduated confused. It was not until the book Secrets of the Soil that things began making sense.
The book introduced me to many new ideas, like the concept of activated water, the importance of nutrient density, the dynamic mineral accumulation of weeds, and the work of Dr Rudolf Steiner and biodynamic agriculture.


Steiner’s lectures on agriculture in 1924, known collectively as the Agriculture Course, deliver a download on the structure for life within the stars and beyond the senses. Steiner was asked by farmers who had adopted conventional growing methods to deliver lectures that would assist them in improving the life force of their farms. Anyone interested in agriculture should read them.
The premise of biodynamics is that the physical world is precipitation of a spiritual reality. Rather than our bodies being our identity, our true self is rooted in the spiritual world. Like homoeopathy, rather than working on the physical body like genetic modification and synthetic fertilisers, the biodynamic preparations BD500-508 work on the farm’s life force (etheric and astral).
What Steiner was advocating for in his development of the biodynamic method was to view the farm as an organism. The impact of the preparations comes from the energetic and organisational alignment of the farm, through the human farmer, with the stars. So, through potentisation, the BD preps were designed to concentrate the frequency of the organ wishing to be strengthened on the farm to align and resonate with the frequencies of the celestial bodies/organs and, therefore, the power of the cosmos.
These ideas may seem foreign to those who have not experienced working with the life force in farming. It took me many years of study and practice to overcome my scepticism, but consider this - unless we are open to the concept of life forces, we can’t work with them. Our willingness to entertain these ideas with our consciousness allows us this opportunity. But we must recognise that the state of our consciousnesses has a tremendous impact on the quality of our plants for human health.
All of us alive at this critical moment of humanity are agents of a future calling, but we are crippled in the cage of our ideas. Illness and ignorance are perpetuating; people are parlaying myths that have no power over us except for outsourcing our agency and poor perspective. Those who can see what is happening are speaking up and acting out. Still, collectively, we have been hypnotised into a trance, which Mattias Desmet calls “mass formation” in his book, The Psychology of Totalitarianism.
As we awaken from our spiritual slumber, it is time to recognise our place in the universe, realise the power and potential of ego consciousness, and, therefore, our responsibility as individuals and species. It is time for us to take our righteous seat at the table within the natural world with our head up and our hearts open.
“When the soul begins to understand the wonder constructed by the wisdom of the cosmos — when she attains thoughtful clarity and illumined knowledge then the sun may represent the most glorious symbol of this inner awakening which opens for the soul the outer world through the medium of the senses.”
- Rudolf Steiner, April 12th , 1906, Berlin
All of us alive at this critical moment of humanity
Here is a concept that can save our species – the Earth is an organism.
The Earth is alive with energy, charged and enlivened by the sun. Earth breathes through the seasons, inward, where the breath peaks inside the Earth during the winter solstice and outward again through the spring until the bottom of the breath during the summer solstice. We see this living rhythm in the tides of the oceans or our breathing.
As it is with all living organisms, there is no centre of control. Centralised systems are vulnerable and are not sustainable, but there is strength in diversity. For instance, the organs of the physical body work decentralised through the nervous, rhythmic, and metabolic systems. These systems maintain the entire processes of the human organism and function with a certain autonomy and authority, with no absolute centralisation.
This is also the function of a healthy society. Our human systems of rights, economy, and culture have become conflated and compromised to the point where society has become sick. This is why church should be separated from state, and corporations should not be recognised as people.
The regeneration mechanisms at our disposal demand an activated public operating in our agency, but we are mostly dormant. We seem to fear thinking for ourselves. This is a function of many things, a primary factor being nourishment and the deficiency of life force in our food.
The new frontier of agriculture is the effect of human consciousness on our environment. The most potent weapon we have for thriving humanity is happy farmers.
As in all human endeavours, the farmer’s happiness is a huge factor in how plants grow; countless books and researchers have documented this over time. If we can consider the crops that we tend almost as our children, we can understand that when the parent is happy, the children are happy. It’s the same with plants.

What we need to do is bring specific focus to the effect of the human heart on plants. If the grower dominates and pushes plants out of demand, fear, and manipulation, there is no love in the food, which results in malnourishment and disease. However, if the grower expresses love through their food, it allows for a different transformative property in its ability to nourish.

We are our only hope. Above all, it is our ideas that will save us
Farmers are very much like sacred priests that can change the course of society by projecting love into their food and charging the consciousness of the people who consume it. This is now the work of the modern farmer.
There are tremendous economic and chemical forces in our way. What is essential is building new systems that make the existing ones obsolete. To fulfil this mission of growing food capable of inspiring human intuition and imagination into action, we must radically change the incentives around farming. We must recognise the vital role of farmers in healthy people and the planet. Buying local food is a start, but we must do more.
Farms are becoming fewer and older by the day. How do we make farming a desirable career again? How do we make it possible to access land, build incentives for high-quality food production to encourage regenera -
tive methods, showcase agriculture in urban environments, and make it easier for the youth to get their hands in healthy soil?
Kiss the Ground is undertaking its Regenerate America campaign to raise awareness for the ability of regenerative agriculture to engage so many of the challenges we face. Corey Booker has introduced a package of bills in the Senate to reform the US food system; this is a start.

Dr Zach Bush is the co-founder of Farmers Footprint. He posed a question that may be one of the most important questions ever asked – what are we willing to live for?
This question generates the fortitude to persevere through the challenges before us and shines a bright light on a sustainable future for humans on Earth.
We are our only hope. Above all, it is our ideas that will save us. 3
Bio
Evan Folds is a regenerative agricultural consultant with a background across every facet of the farming and gardening spectrum. He has founded and operated many businesses over the years - including a retail hydroponics store he operated for over 14 years, a wholesale company that formulated beyond organic products and vortex-style compost tea brewers, an organic lawn care company, and a commercial organic wheatgrass growing operation.
He now works as a consultant in his new project Be Agriculture where he helps new and seasoned growers take their agronomy to the next level.What we think, we grow!
Contact Evan at www.BeAgriculture.com or on Facebook and Instagram @beagriculture
We must recognise the vital role of farmers in healthy people and the planet. Buying local food is a start, but we must do more
ushrooms can be grown using various methods, but no matter the process, there has to be starting material.
Starting material consists of mycelium of a pure culture in a test tube, on an agar plate, or macerated in a syringe. But that pure culture itself has to come from somewhere. A pure culture of a mushroom fungus can be derived from a mushroom’s tissue culture or by propagating spores collected from a mushroom. A growing number of vendors offer spores of many mushroom-forming species in syringes, on spore prints, or in vials.
Preloaded spore syringes are probably the most convenient way to inoculate a substrate with minimal equipment. One installs the needle on the syringe body (if it is not pre-installed) and injects the contents (using some semblance of sterile technique) into a bag or jar containing sterile grain, straw, sawdust, wood chips, or other media. Pretty straightforward.
Syringes provide an easy method of performing the multi-spore technique of generating mushroom-producing dikaryons. Not all species (e.g., Agaricus bisporus, the commercial button mushroom) require the formation of a dikaryon to be able to produce mushrooms, but others do. To generate random dikaryons, many spores are grown near each other, resulting in fusions between hyphae from spores having compatible mating types. When injecting directly into a fruiting substrate, expect genetic diversity in the resulting fruit bodies because mycelia of many different genetic combinations will colonise the substrate.
A way of directly isolating dikaryons is by spreading spores from a syringe onto an agar surface and collecting hyphae from regions where primordia form. Primordia can take up to a month or more to appear. Primordia are tiny bundles of hyphae formed by successful matings that show up as dot-like structures on the mycelial surface. Primordia can later develop into mushrooms.
Isolation of colonies derived from single spores is readily accomplished by applying a small amount of spore solution from a syringe onto an agar surface and diluting it with additional sterile water. The concentration of spores in a syringe can vary widely, so some experimentation is required to get the dilution just right so that individual colonies can be picked off the agar surface before fusing with a neighbour.
So, besides spores, what exactly do you get with a spore syringe? The spores are most often suspended in sterile distilled water, providing a nutrient-free environment that, although well-hydrated, is not conducive to germination. Spores of many fungi will germinate on plain water agar, but germination requires active cellular respiration and, therefore, oxygen. Spores on an agar surface have access to adequate oxygen but spores surrounded by high-purity water in a syringe do not, so they tend to remain dormant. Dormancy is well maintained under typical refrigeration at around 4°C. Spores can remain viable in a syringe for 18 months or more if cold.
A bit of surfactant (detergent) added to a spore solution will help prevent spores from sticking and clumping together, and you may find some vendors using it. This is only advantageous in the case above, where single spore isolates are desired. Should anything else be added to the spore solution to preserve the spores or kickstart germination? Probably not. The point is to keep them dormant. They don’t need an energy source built-in since that will be provided once released into a nutrient-rich environment. 3
Philip McIntosh holds a B.Sc. in Botany and Chemistry from Texas State University and an MA in Biological Science from the University of Texas at Austin. He has been publishing professionally for over 30 years in magazines, journals, and on the web on topics relating to botany, mycology, general biology, and technology. As a STEM (Science, Technology, Engineering, and Math) educator, Phil enjoys working with students to help them advance their knowledge and skills in relevant fields of learning.
Preloaded spore syringes are probably the most convenient way to inoculate a substrate with minimal equipment





When we saw the views before buying our house, we didn’t anticipate all the gardening challenges on a steep slope. The property ticked many sustainable living boxes; water tanks, solar panels, a shed, flat areas around the house, and an established orchard on the slope below. However, as we started to design the kitchen garden and work with the site, it became apparent that a sloping block can present MANY challenges!
We are working with the positives of a sloping property, like incredible views, sunlight all year, cooling breezes, multiple microclimates, and the opportunity to harvest water and free energy. The two biggest issues we have had to face are access and watering. The soil is clay on a rock base. So, while it is minerally rich and holds moisture well, digging is a nightmare! We have flat pads where the house and shed are, so lawn areas have trees, shrubs, and hedges.
We are using several strategies to tackle the access, create more flat functional zones for gardens and recreation, get water where needed, and prevent soil erosion. We aim to make the property easier to navigate and enhance its visual appeal by adding value and functionality.

Behind the shed, we inherited a flat area and a timber sleeper raised bed, our starting point for growing food. Adding more raised garden beds made sense as we couldn’t dig down. We opted for 2m x 1m DIY kits that were economical and took five minutes to assemble. They are aesthetically pleasing and narrow enough to fit in a tight space. I squeezed in a block of four and designed minimum-width paths so I could still access either side with a wheelbarrow for maintenance. This bought us an extra 8m2 of growing space. I also added a tiered stand with shelves and self-watering rectangular planters to take advantage of vertical space. These suit shallow-rooted salad greens, herbs, and flowers.
Meanwhile, I have a huge temporary container garden with plants that need new homes! I have set up a mini nursery at the base of the rock retaining wall between the house and the shed. It has easy access to water and provides shade relief during our long hot summer. I will gradually transplant these ‘renters’ to permanent accommodation on the terraces below.

There were two narrow weedy terraces below the shed with rock retaining walls. I used two strategies to turn the weedy grass into a garden. Firstly, hand digging (call me crazy) all the worst weeds and grass out of the top terrace after rain. I got a great workout,

and it was my first opportunity to work with the native clay soil. It was heavy, so I decided to sheet mulch most of the terrace to make the next stage of establishing healthy soil easier. Since we’d recently moved here, I had plenty of cardboard boxes to lay over the grass and smother it. I covered this with composted manure, minerals, and a thick layer of mulch. All the rain helped activate the cardboard breakdown into carbon. So within a few months, I could establish a food garden quickly with fruit trees, support species, perennials, fruiting crops like tomatoes, eggplant, capsicum, and lots of herbs and flowers.
On this terrace, I only had room for a narrow pathway. I planted on both sides, limited by the upper and lower rock walls. I had no steps, so I had to access it via a slope at one end. We have since had steps built and will be installing these soon. While steps remove some of the planting areas, access takes priority.
as we started to
the
garden and work with the site, it became apparent that a sloping block can present MANY challenges!



















Next up, I started work on the terrace below the Perennial Terrace and shed. It is relatively flat but slopes towards our water tanks with no retaining wall. My initial plan was to work on the soil. I sheetmulched this area and planted pumpkins and sweet potatoes. At one end, I planted my three dwarf banana cultivars into giant grow bags, an experiment to see if they can produce fruit in ‘pots.’ So far, they have all thrived in 100L bags, but I’d use 200L next time. I planted potatoes into grow bags and let them sit in this area.
As it’s turned out, pumpkins are like naughty teenagers looking for any opportunity to escape! They scrambled UP the rock wall into my Perennial Terrace Garden and down around the water tanks. Despite their antics, I’ve let them have some additional space since we’ve harvested well over 100kg of pumpkins from this small narrow bed. I will add more compost and thick mulch to build up the soil; eventually, we will retain it. Meanwhile, it will remain the spot for our ‘wild child’ crops to come and go seasonally.
On this same level, below the house, we had multiple issues. There was no retaining wall, just an irregular battered slope with weeds and rocks. It was challenging to whipper-snip and maintain. There was a flat pad below this slope, but it was a weedy nightmare and unattractive. The lower side had bush rock, and the area wasn’t wide enough to be functional. However, it had great potential.
The bluestone rocks here are like icebergs with a small cap showing on the surface but a titanic-sized ton of rock submerged. My husband
took on the challenge and got heavy equipment to excavate. We created a wider flat pad and new retaining walls. He poured a concrete pickleball court with planters and garden beds by extending the pad just above our sloping orchard.

We used 1.2-ton concrete blocks to create the main retaining walls and smaller besser blocks for the low retaining walls and planter boxes. The concrete blocks do have an industrial look, but sandstone was hideously expensive and hard to build with as they are not even. We couldn’t dig holes for steel posts into the rock, so for the most part, sleeper retaining walls were not an option. We had to think creatively.


We’ve installed steps at either end so I can get down to my new Food Forest, the court, and the orchard quickly and easily. Drip irrigation systems are being installed next.
The result? We’ve redesigned an unsightly area, created a new terrace for my Food Forest, a pickleball court for exercise, and removed the need for weeding or high maintenance. The raised planter near the water tanks has steel posts and horizontal wires for my passionfruit to grow as a living screen for this utility area. The trellis will eventually wrap around to the Banana Terrace, and I’ll plant a colourful garden. We will paint the concrete blocks used for the retaining walls to soften the hardscapes and complement the court colours. The capping provides ample seating for watching the game or enjoying the view.
I had plenty of cardboard boxes to lay over the grass and smother itBanana and pumpkin lower terrace below the Perennial Terrace Garden Sheet mulching the lower Banana and Pumpkin Terrace garden










The rock walls are made from rocks originally excavated when the house was built. To soften these and deter snakes from using them as habitat, I have stuck cuttings of Dogbane (Plectranthus caninus) into the clay soil between them. This drought-hardy plant fills in the gaps, adding pops of seasonal colour. It survives on rain and dew.

The steepest part of the property is our fruit tree mini orchard and ornamental tree zone. It isn’t easy to walk around. However, we still need to maintain and harvest from our fruit trees. The clay soil can become incredibly hard and dry during summer and drought. After the rain, though, the weeds sprout up! Covering it with mulch around the fruit trees has been a priority to lock in moisture, prevent weeds and protect the soil from erosion. Trees have also benefited from the organic matter and the microbial communities helping feed them.
Unfortunately, much of the ripe fruit rolls down the hill to our bottom fence! The mulch is slowing it down, and hay bales have been a temporary measure to put the brakes on and prevent erosion and nutrient loss.
• Create terraces and retaining walls to increase flat usable areas.
• Add steps for easy access.
• Build raised garden beds into terraces or narrow, awkward areas.
• Use swales to grow on contour, harvest water passively, and reduce erosion.
• Use hay bales as temporary barriers to stop fruit from rolling down the hill while capturing moisture. They can also double as strawbale gardens.

• Excavate and infill to create more usable space.

• Consider mulching or an automatic mower if mowing is impractical or too dangerous.
Watering this zone is challenging as it’s too steep to get big equipment in safely. So, we plan to install a couple of IBC 1000L plastic tanks to take the overflow of rainwater from our main tanks. We’ll use this to water, and liquid fertilise our fruit trees. Hopefully, we’ll enjoy a bigger harvest in years to come.
Finally, our block is on a corner at the top of a very steep hill. Our verges were one of my husband’s first challenges when trying to work out how he would mow safely. His genius solution was a Husqvarna robotic mower! We affectionately named him ‘Tom’ as he not only solved our dilemma by navigating the steep slope but works day and night in any weather. This has been brilliant in summer when the grass seems to grow overnight. We plan to get another model for the lower-sloping orchard once we create barriers.
While sloping blocks have their challenges, they also offer incredible potential for landscaping to optimise garden spaces, attractive views, and spaces to enjoy. Besides, it keeps us fit, and hills are cheaper than gym fees! 3
BIO Anne Gibson, The Micro Gardener, is an author, speaker and urban garden community educator on the Sunshine Coast, in Queensland, Australia. Anne is passionate about inspiring people to improve health and wellbeing, by growing nutrient-dense food gardens in creative containers and small spaces. Anne regularly presents workshops, speaks at sustainable living events, coaches private clients and teaches community education classes about organic gardening and ways to live sustainably. She has authored several eBooks and gardening guides. Anne shares organic gardening tips and tutorials to save time, money and energy on her popular website - TheMicroGardener.com
Covering it with mulch around the fruit trees has been a priority to lock in moisture, prevent weeds and protect the soil from erosionDogbane cuttings planted into the retaining wall now fill the gaps and soften the rock face Home Pharmacy Garden on a flat terrace next to the house




Basement growing dramatically reduces our food miles into “food steps”, which must be recognised and applauded as a major step towards regeneration

Increased soil carbon sequestration, amplified biodiversity through polycultures, enhanced nutrient cycling, and improved water-holding capacity are just some of the benefits that most regenerative farmers seek by employing agricultural practices that mimic Nature. But do these apply to the basement gardener growing their food or medicine in a 5ft x 5ft Mylar grow tent?
The thought that my basement garden could contribute to climate chaos seems a far stretch, but take a deep dive into standard practices by growers, and you can quickly see that you may be part of the problem. Under a hypothetical visit to Eric Coulombe’s (Garden Culture Magazine President) grow tent, we will place a regenerative lens on basement gardening and look at ways of growing with a lighter footprint.
Arguably, one of the greatest downfalls of our current dysfunctional food system is the distance our food (or medicine) has to travel before reaching us. Basement growing dramatically reduces our food miles into “food steps”, which must be recognised and applauded as a major step towards regeneration. More so, many medicinal indoor growers have taken their skills from their basements to their backyards to produce fruits and vegetables for themselves and others, thereby increasing community food security.

Walking downstairs, a dank aroma greets your senses; not your Grandma’s basement smell, but rather the scent of soil in spring, like you are in a greenhouse. You pass a shelf with lots of plastic bottles -- some are liquid fertilisers or pH adjusters, and others are pesticides in case your garden has the occasional pest or pathogen visit. As you approach the grow tent, you dance around some bags of peat moss and perlite. Unzipping the tent, a wave of heat hits you from the High-Pressure Sodium (HPS) light, and you look over nine 6-gallon pots with gorgeous plants all praying towards the light.
Upon closer observation, you see a few fungus gnats flying around and the start of what could be an aphid infestation. Does any of that sound familiar? Substitute the growing media with a nutrient-dense “Just Add Water” Super Soil or coco coir, and the results could be similar because the system is designed for single-use growing; a one-and-done growing media that is then either thrown away in the backyard or re-purposed/recycled for garden beds. But, there is a better way - Horizonal Living Soil Organic Beds.
Leighton Morrison, soil biologist and biomimicry advocate, introduced the concept of a horizon-bed system. If you asked him about the initial reaction to his idea, he will tell you people laughed. Perhaps an idea ahead of its time, but as “science” catches up and better understands Nature, the importance of sand, silt, and clay and their interactions with soil life can no longer be ignored.
It is important to remember that most container gardens use a grow media equivalent to a potting mix with peat, coco, perlite, and perhaps some added minerals and compost, often with an organic matter content above 50%. In contrast, natural field soil may be close to 45% minerals with, at best, 5% organic matter (assuming 50% of the soil is comprised of air and water). Interestingly, until the mid1960s, most greenhouses, government and academic research institutions used natural field soil (albeit fumigated with a toxic soil-life-killing pesticide or by extreme heat) in clay pots until Cornell University popularised the use of peat moss, perlite, and compost as a lighter weight, suitable alternative.
The first step is observing Nature and how plants grow, their surroundings, behaviour, and likes and dislikes


So, how do I mimic Nature in my grow tent? The first step is observing Nature and how plants grow, their surroundings, behaviour, and likes and dislikes. The next step is highly dependent on the creativity of the grower, and it is impressive how ingenious growers can be when re-creating what they have observed. Another critical point to remember before designing your tent garden is that agriculture is unnatural. Growing food and medicine under artificial light is not natural nor optimising yield or even harvesting fruit or flower before seed production. Therefore, don’t get overly bogged down on not perfectly mimicking what the great outdoors offers. We have our own agenda and are constantly tweaking “Nature” for our benefit.



With that in mind, creating an opportunity for sub-irrigation (bottom watering) is worth considering. Finding access to a 4ft x 4ft flood tray with no drain (perhaps a kiddie swimming pool) can serve as a reservoir for sub-irrigation if desired. The next decision would be the choice of material for the bed. Fabric beds made of non-woven geotextile polypropylene work great, and there are many brands available, but best to choose ones that have reinforced seams, are UV-resistant (especially if your LEDs have UV-A or UV-B), and are BPA-free. Some companies have developed a “living soil liner” impermeable to water yet allowing air exchange; this is critical, or many fabric beds will allow living soils to dry out and make an inhospitable environment for microbes to thrive. Before purchasing a fabric living soil bed, ensure the dimensions fit your sub-irrigation flood tray.
The horizonal-based living soil bed system is loosely designed by Nature but condensed to fit into the 18-inch depth of the bed. The bottom layer is the E horizon (Elluvial), comprised of gravel, rocks, and sand. Functionally, the E horizon serves as an aquifer, a water-holding area that will store water to be wicked up by the soil and roots above. Ideally, you want gravel and stones that vary in colour, and similarly, you will add coarse sand until you have about a 2.5-inch depth of sand and gravel. Avoid fine white sand because it lacks most minerals, and the fineness will limit aeration. The sand functions as a filter and prevents fine particles of organic matter to enter the E horizon, where it would create an undesired anaerobic environment. If you oppose using gravel, stones, and sand, you could use pumice, lava rocks, perlite, and sand, but you may compromise the layer’s ability to filter organic matter.


Next up is the A horizon, which will be approximately 5 inches and composed of sand (50%), silt (13%), clay (17%) and about 20% organic matter, essentially creating a nice sandy loam soil. For those interested in capturing the “terroir” of their area, it can be an opportunity to collect the sand, silt, and clay from around their region. Once again, increased mineral diversity comes from sourcing various clays from different areas in a range of colours. You can collect silt along river sides and streambanks, but if difficult to source, you could try finding the finest of

glacial rock dust as a silt substitute. The organic matter can be the same material used above (the O Horizon), or you could add coarser material like composted bark mulch, aged manure, charged biochar, and perhaps some bulkier compost. After thoroughly mixing all of this material, layer on top of the E horizon, and if so desired, spray some aerated compost tea or extract.
Lastly is the 10-inch O-horizon, your organic matter layer, which can be peat moss, coco coir, or worm castings-based potting mix like any nutrient-dense super soil. Organic fertilisers like alfalfa meal, bone meal, kelp meal, insect frass, hen manure, rock powders (e.g., limestone and basalt) and yucca extract (as a wetting agent) will provide ample nutrients for your plant’s life. You can add soil probiotics like bacterial inoculants or mycorrhizae for increased nutrient availability if desired.



Nature abhors a vacuum, so you may choose to keep your horizonal living soil bed system covered by using a living mulch (e.g., Dichondra, Hairy Vetch, Creeping Thyme,
WARNING!
Chamomile, Sweet Alyssum, etc.) or dead mulches (e.g., straw, compostedramial wood chips). Living mulches add to the biodiversity both above and below ground and can provide a habitat for beneficial insects. Dead mulches can provide nutrients through decomposition and help maintain a moist environment on the soil surface for beneficial microbes and help retain water.
Bringing the great outdoors inside is not for the faint of heart, but once established, you can cultivate this system for years with minor amendment additions. Perhaps more importantly, a significant reduction in external inputs like bottled nutrients and single-use growing media is needed. As you take this step towards regenerative basement gardens, be fair-warned that lightening your footprint is contagious, and you will look for more ways to be part of the solution. 3
BIO Av Singh, PhD, PAg advocates regenerative organic agriculture serving various organisations, including Regeneration Canada, Navdanya, and the Canadian Organic Growers.

As you take this step towards regenerative basement gardens, be fair-warned that lightening your footprint is contagious, and you will look for more ways to be part of the solution

Everest Fernandez takes a real-world look at the problem of “nutrient lockout” in recirculating hydroponics systems.
Indoor hobby growers typically pay a lot for their hydroponic nutrients, whether in one bottle, two, three, or four—or as bags of dry powder. The common notion or expectation among growers is that, in return for all this financial outlay, the headache of consistently achieving optimal nutrition for our plants has been taken care of by some diligent lab coat-wearing formulation chemist on a light industrial estate somewhere. All the work that remains is measuring each part, mixing, stirring, adjusting pH, and everything should be balanced—all the mineral elements your plants could desire are in the solution.
More often than not, everything will run smoothly—especially if you have a good water source (the most often overlooked “additive”) and start at just a quarter or half of the full-strength recommendation. But sometimes, it’s anything but plain sailing.
From stunted growth, deformed leaves, and interveinal chlorosis to necrotic spots, leaf curl, and burnt leaf tips and margins, this is not the “convenience” you paid for.
Bad batch? It’s tempting for novices to scapegoat the nutrient brand as it absolves the grower of any responsibility—but, after visiting more than a few nutrient factories, I can attest that it’s improbable they messed up—especially if you’re buying from a reputable manufacturer with a raft of quality control procedures in place. Your grow store has heard it all before too. At best, you’ll be politely questioned about your growing environment, media, water source, and irrigation practices and leave with your tail between your legs.
Nutrient lockout is when essential elements become unavailable or inaccessible to plants, despite their presence in the nutrient solution. It is essential to clarify that lockout does not imply a lack of nutrients; rather, it indicates factors that prevent nutrient uptake and utilisation. Several factors contribute to nutrient lockout in hydroponics, including pH-induced precipitation, nutrient imbalances, and salt buildup in the substrate.
Precipitation refers to an element forming an insoluble compound and dropping out of the solution. Remember, for any element to be taken up by plants, it needs to be dissolved. The solubility of specific nutrients is directly affected by the pH of the nutrient solution and growing media (if used). Dust off your hydroponics textbooks, and you may find iron, zinc, and manganese cited as examples of elements that become less available in alkaline solutions (high pH), but this refers to relatively cheap ‘old school’ sulfates (iron sulfate, zinc sulfate, and manganese sulfate).
Modern hydroponic stock solutions typically use ‘chelated’ forms instead. Chelates are a chemical ‘cage’ that maintains availability while protecting the iron, zinc, or manganese from fluctuations in pH that would otherwise cause them to become insoluble.
The three most popular chelates used in hydroponic nutrients are EDTA, DTPA, and EDDHA. Each chelated form offers distinct benefits and drawbacks. EDTA is cheap and offers’ entry level’ protection against precipitation. DTPA offers higher stability over a broader pH range compared to EDTA but can still undergo dissociation and lose its chelation capacity at higher pH values. EDDHA is the best-performing chelate in maintaining availability across the widest pH range, including alkaline conditions, but it’s also the most expensive. EDDHA also requires more agitation to achieve solubility.
If your nutrient manufacturer is really ‘sparing no expense’, look for EDDHA on the label.
These days, hobby growers using recirculating hydroponics systems are more likely to fall foul of pH-induced precipitation of calcium and magnesium—two highly reactive elements that often cause growers issues.
Remember, in recirculating hydroponics, the pH of the feed solution tends to rise over time; this is due to several factors, including the uptake of nutrients (plants tend to uptake positively charged ions more than negatively charged ions leading to an accumulation of anions and an elevated pH) and alkaline water sources. Even plant exudates, initially acidic, can turn into pH-rising carbonates and bicarbonates once microorganisms metabolise them. If you’re using beneficial biology in hydroponics systems, this is something to watch out for.
It’s tempting for novices to scapegoat the nutrient brand as it absolves the grower of any responsibility
Excessive application of certain nutrients, such as potassium or phosphorus, can interfere with the uptake of other essential elements like calcium, magnesium, zinc, and iron


Both calcium and magnesium become less available in even slightly alkaline solutions (pH 7.5 or higher).
As the concentration of hydroxide ions increases, calcium and magnesium ions are more likely to form the precipitates, calcium hydroxide, and magnesium hydroxide.
LED growers running warmer air temperatures in their grow rooms should consider chilling their nutrient solutions (around 66°F or 20°C is optimal) or positioning their reservoirs outside the grow room. Warmer air temperatures lead to warmer nutrient solutions which, in turn, are more prone to increased microbial activity, accelerated nutrient uptake, and increased breakdown of carbonic acid—all of which can speed up the rise in nutrient solution pH. To mitigate these inevitable temperature rises, use the largest size reservoir that is practical. Adding “moaaaarrrrr calmag” will typically lead to high nitrate levels ... which brings me to …
Imbalances in nutrient concentrations can also contribute to nutrient lockout. Excessive application of certain nutrients, such as potassium or phosphorus, can interfere with the uptake of other essential elements like calcium, magnesium, zinc, and iron. Maintaining a balanced nutrient solution is essential. Carefully follow recommended application rates and avoid overzealous use of additives—especially calmag and PK boosters. Regularly monitoring nutrient levels and adjusting the solution will help prevent nutrient imbalances and improve nutrient availability.
When topping up your reservoir, mix up a half-strength nutrient solution and top up with that, rather than adding water and applying extra nutrient products. Plants uptake nitrates, ammonium, phosphates, potassium, and manganese very quickly, whereas elements such as calcium and boron are taken up more passively and slowly, or at least proportionally, to transpiration rates. Over time, this can lead to an excessive supply of calcium and boron in the solution—especially for calmag lovers—which invariably antagonises magnesium uptake, leading to the telltale interveinal chlorosis. Often, this leads inexperienced growers to add more calmag, exacerbating their magnesium lockout issue further.
Coco coir is an excellent growing medium, but growers must know its tendency to claw back calcium and dump potassium into your nutrient solution. If you repot your plants towards the end of the
vegetative period and start using PK boosters too early, you could double-dose your plants with potassium and crowd out calcium. Finding plants exhibiting symptoms of calcium lockout is now a daily occurrence when browsing Instagram and other social platforms. Necrotic spots, leaf deformities, and weak stems are everywhere! Use a coco-specific nutrient formula and high-quality, double-buffered coco coir.
In recirculating hydroponic systems, pH rises over time due to nutrient uptake and alkaline water sources. Increased air temperatures can exacerbate the rise in pH, leading to nutrient lockout. Growers should monitor and maintain the pH of the nutrient solution within the optimal range (typically 5.5 to 6.5) to prevent precipitation and ensure nutrient availability. Additionally, maintaining cooler nutrient solutions by chilling them to around 66°F (20°C) or positioning reservoirs outside the grow room can mitigate the effects of temperature-induced pH rise.
Improper irrigation practices can lead to the accumulation of salts in the root zone, impeding nutrient absorption. High salt concentrations cause water to move out of the plant roots, making it challenging for plants to uptake nutrients. Adjusting irrigation practices, such as employing appropriate watering volumes and frequencies based on the specific growing media (e.g., Rockwool or coco coir), can help mitigate salt buildup. Ensuring adequate runoff to remove excess salts from the root zone is vital for maintaining nutrient availability.
Nutrient lockout can pose significant challenges in hydroponic systems, affecting plant growth and productivity. By understanding the underlying causes and implementing effective nutrient management strategies, growers can mitigate the risks of lockout. Balancing nutrient concentrations, monitoring pH levels, managing temperatures, and adopting proper irrigation practices are essential for maintaining optimal nutrient availability and ensuring healthy plant development in hydroponic cultivation.
Ask your local grow store for nutrient products specifically designed for recirculating hydroponics. 3
is when essential elements become unavailable or inaccessible to plants, despite their presence in the
Improper irrigation practices can lead to the accumulation of salts in the root zone, impeding nutrient absorption
ou prune and stake your tomato plants, but what about zucchinis? This garden technique is easy, will help protect against disease, and lead to better yields! Find this awesome how-to guide and

Azucchini plant is a lazy gardener’s crop. For very little work, the payout (AKA the yield) is enormous, and nothing beats the taste of one fresh out of the garden. But it turns out I may have been a little too lazy growing this crop in past years and that zucchini plants can benefit from pruning and staking.
Yes! Much like tomatoes, your zucchini plants won’t mind having a little trim and TLC throughout the growing season.
The benefits are many, including reducing the risk of disease, such as powdery mildew, which is inevitable with zucchini plants.

Leaves won’t sprawl across the soil, meaning fewer pathogens will get to them. And it allows for better air circulation, which is a good thing for fruit production!
The technique is also a major space-saver out in the garden. Zucchini plants tend to take over rapidly; pruning and staking make them more compact and helps them grow up instead of out.
 Prune Leaf Stems With Shears tie stem to stake
Prune Leaf Stems With Shears tie stem to stake
This is a job that is easiest done as you initially plant your zucchini. If you’re a little late to the game, no worries! Just be careful not to disturb the roots.
Plant a four or five-foot stake close to the zucchini stem and gently tie with some garden string or tomato ties. As the zucchini continues to grow, keep securing the stem in increments.

Pruning zucchini isn’t a huge project because you shouldn’t remove too many of the leaves.
The fruit needs the leaves above to grow; only remove the ones below the first zucchini blossoms.
In addition to the leaves, remove their stems. Do this with a sharp pair of garden shears and clip right at the main stem. It’s not difficult to do, as you’ll notice the stem is hollow until it hits the plant’s main stem.

The result is a zucchini patch that looks nice and tidy!

As the growing season continues, watch for the development of powdery mildew and remove any diseased parts of the plant. Discard them into the garbage - never the compost.

A healthier plant could very well lead to a better harvest. Grilled, stuffed, or grated into bread or sweets; you’ll enjoy lots of zucchini for months to come! 3
tidy zucchini patch!
Catherine is a Canadian award-winning journalist who worked as a reporter and news anchor in Montreal’s radio and television scene for 10 years.A graduate of Concordia University, she left the hustle and bustle of the business after starting a family. Now, she’s the editor and a writer for Garden Culture Magazine while also enjoying being a mom to her three young kids. Her interests include great food, gardening, fitness, animals, and anything outdoors.

& Indoor
This seemingly random desire to grow food has become more than just a hobby; it’s a near obsession
Astrange sense of desire and urgency came over me one day when I was on Galiano a few years ago, and suddenly, I knew I needed to start growing food indoors. I needed to start fixing what was seemingly becoming an issue for many Canadians: access to fresh food. I immediately contacted friends in the growing industry to decide how to move forward with my indoor farm. This seemingly random desire to grow food has become more than just a hobby; it’s a near obsession.
Part of my obsession with having year-round access to all types of food is creating the right, cost-effective environment. I have been experimenting with this for three years and have spent a lot of time trying to perfect indoor food production. There is no reason for everyone not to produce food on a small scale at home. Over the years, society has removed people from nature; it’s time we reintegrate into the art of growing food for ourselves.
Small-scale indoor farming is relatively easy and cheap and doesn’t involve much work. However, as with most designs, the only thing the same is they are all different. We can grow indoors in many ways; one method is not better. Whether using hydroponics or soil, choose the right approach for you. On my farm, we use soil-based media. But if I lived in an apartment, I would seriously consider a media-less environment. Below, I will describe a simple and successful way to grow microgreens indoors using soil.

At Galiano Grow House, our primary focus for indoor food production started with microgreens. These small and fastgrowing greens pack a substantial nutritional load and grow quickly. They are typically ready to eat in 8-14 days and require few nutrients and little artificial light. For microgreens, our typical crops include speckled peas, sunflowers, radishes, lentils, popcorn, fava bean, and buckwheat. My favourite, and one of the easiest to grow, is sunflower sprouts.
• LED clone lights (2 @ 20 Watts per level)
We use AELIUS LED
• 18” -24” by 48” rack for growing, ideally with five shelves
• 20-30 Quad thick (ideally very thick as they last longer) trays
• Seed (preferably local and organic)
• Hypochlorous acid generator
• Misc. hand tools, knives, etc.
WATER TEMPERATURE
Water the prepared trays with warm (not hot) water (this is more important in the winter season).
Always water the plants with room temperature water. Rince harvested microgreens with the coldest water possible before drying.
HYPOCHLOROUS
• The hypochlorous must be made every day and used fresh.
• Make the hypochlorous with room temperature water.
• Trays that only served as a lid can be sprayed with hypochlorous and used again without washing.
Prepare by mixing:
• 1L of water
• One teaspoon of sea salt
• One teaspoon of white vinegar
Plug in the Hypochlorous Acid Generator and activate the first cycle. The Hypochlorous needs two cycles before it is ready.
Hypochlorous Acid Generator

• Peat
• Coco Earth
• Perlite
• 50-gallon container (or any big container)
• 2L pot
• Shovel
• Gloves (optional)
1. The microgreen soil media mix is composed of peat, coco coir and perlite in a ratio of 3-1-1.

2. With the 2L pot, scoop in the three components in this order: Peat-coco-peat-perlite-peat, and keep repeating until reaching the required quantity; always finish with the peat.
3. Mix thoroughly with a shovel.
Store the peat and soil media mix in barrels outside the grow room and cover them with a lid. During the winter, the materials can freeze and harden. Break the frozen clumps with a shovel before using the mix. During more humid seasons, the peat can grow moldy when stored in the bag. When putting the peat in the barrel, mix well so it can oxygenate and dry.
You will need:
• 10’ x 20’ microgreen tray
• Soil media mix
• 2L pot
Using the 2L pot, scoop the soil media mix two times per tray for 4L of soil media per tray. Spread the soil evenly, breaking any clumps as you go.
Add 100g of sunflower seeds to a 750 ml container and fill halfway with a mix of water and silica. Soak for 16-22 hours; if using large sunflower seeds, six hours will suffice.
After soaking, rinse the seeds and water the prepared tray of soil media before planting. Gently sprinkle the seeds evenly throughout the soil mix, then cover them with a clean tray weighted with rocks, wood, or slates so the seeds press into the media.
The day after planting, and every day after that, mist the seeds with water and spray them with hypochlorous acid. Nine to 12 days after planting the seeds, remove the lid and place the sprouts under the grow lights. Gently remove the shells from the greens.
By day 13, the sprouts will be ready to harvest! Do not water microgreens before picking them; water generously the day before. Safely use a knife for harvesting. After, wash and dry them in a salad spinner. The sprouts will last longer if completely dry, so placing them on a tray under a fan is a good idea. Then, collect the greens and store them in a container in the fridge.
Before planting another crop, washing all of your trays well in a sink is essential. Spray them with hypochlorous acid and allow them to dry.

Growing microgreens at home is easy and fun! Enjoy your nutritious harvest in salads, omelets, sandwiches and more! 3
Adam has provided planning and design services for cannabis and hemp cultivation and processing facilities over the last seven years with Stratus. His projects involve outdoor cultivation, indoor cultivation, drying, processing, extraction, storage, bottling and packaging, and more. Living on a hobby farm, Adam loves all plants, including flowers, vegetables, and microgreens, but is most passionate about hemp and is in awe of the fast-growing plant and all of the benefits it offers to humans and the environment alike.

There is no reason for everyone not to produce food on a small scale at home
The parameters of growing with fungi are as varied and unique to the styles and goals of each cultivator. In commercial production and food and medicinal sovereignty initiatives, improving predictability for harvest planning and retaining product quality while increasing yield are significant considerations. Over time, controlled environment cultivation techniques have been developed to mimic the observable ‘optimum’ conditions for the targeted species to thrive. Climate, food availability, and space are the fundamentals; take on any of these for a deeper dive into ‘dialling in’ your grow, and there are prolific opportunities for customisation, experimentation, and exciting discoveries (including the thrilling potential for complete and utter failure!).

As much as cultivators can design, develop, and implement industrial controls indoors, global climate concerns creep in. A rise in extreme weather event frequency has many gardeners reimagining water collection, storage, and efficiency; farmers, foresters, and others are working on carbon sequestration initiatives and alternative electricity generation. All industries are being challenged to optimise excess; high winds and powerful ocean currents are examples of an area where we can give the potential for catastrophe a silver lining.
Increasingly severe storms promote a rise in lightning strikes, which are connected to starting forest fires when they happen over land. Can we find ways to mitigate habitat destruction while encouraging the proliferation of beneficial fungi? If removing some of these fungi as an edible or medicinal ancillary forest crop, how can we ensure we give back to the forest to close this loop?
Historical observations and traditional wisdom transferred through stories, myths, and embedded in languages provide clues to how the relationship dynamics of our natural world work, as translated by our ancestors and transmitted to us across time.
From Pliny the Elder writing in the first century CE about truffles being the product of lightning bolts to indigenous and traditional language names for various species reflecting themes of thunder across the globe, a strong connection between mushrooms and electrical storms has been well established in human record. These events seem to bring along many things our mushrooms enjoy; an infusion of rainwater, rapid temperature, air pressure, humidity fluctuations, and increased available oxygen. For some species known to be ‘pyrophilous’, the accompanying burns provide means to thrive while they act as first responders in renewing these shared habitats.
Regenerative forest harvest strategies, especially on small, individually or cooperatively supervised woodlots, may generally include the intent to leave small branches and leaves to decompose and feed the soil naturally. Here, they will be colonised by all manners of fungi, as are the buried roots of the removed trees, and this diverse cast performs their roles
to break down, recycle, and feed their cohabitating plant species. However, allowing excessively dry tinder to accumulate may not be practical, given the time of year and fire risk.
While recognising the risk of equipmentrelated sparks (chainsaws, for example, are both a tool with which to fight the spread of wildfire proactively and are the unfortunate cause of many ignitions each year), strategic collection of branch wood for chipping and use in gardens is one mechanism for mitigating burn risk.
At the same time, this is a step toward making an intentional habitat for species of mushrooms with which you particularly wish to relate. By inoculating this chipped wood with beneficial fungi and supporting its establishment in a shared ecosystem with other cultivation companions, a hazard is regenerated as a valuable resource.
If rebuilding soil with an enriched substrate, like King Strophariainoculated woodchips, extra attention will likely be paid to moisture retention in those patches or beds.
Consider interplanting with nitrogen-fixing grains and grasses, particularly in a corn, bean, and squash patch, where the large leaves of the squash can shade the woodchips. Locating ‘moats’ of these layered mycelial mats around the garden may provide an extra reserve of water for thirsty roots and encourage worms and other beneficial soil companions to move into the area.
Although there is no requirement to intervene in the natural advancement of the introduced mycelium through its life cycles, tactics may be deployed to produce an especially vital and robust specimen capable of forming many mushrooms. This incarnation of the sample propagated from a liquid or other source culture can be put through fitness training, not unlike how a cultivator will prune or bend plants as they grow.
Conceiving of using a new technique to steer mushroom formation in inoculated logs or bags is not strange to the experienced mycoculturalist, considering these grow styles often deploy some soaking or striking method to encourage fruiting. Other than providing a suitably humid and well-drained habitat and giving the intended species a head start in establishing itself in the substrate, it may be less imaginable to prompt a soil-level patch to fruit.
Increasingly severe storms promote a rise in lightning strikes, which are connected to starting forest fires when they happen over land. Can we find ways to mitigate habitat destruction while encouraging the proliferation of beneficial fungi?





Experimenting with the effects of electricity on vegetative plants has fascinated botanical enthusiasts throughout human history. Modern science has yet to agree on an efficient method of applying dosed voltages or the effectiveness of adding conductive ‘pathways’ for directing naturallyoccurring currents to flow with intention through the growing environment. Still, regenerative cultivators are always seeking new ways to connect with the greater energy transformation systems and, informed by fresh perspectives, remain open to reimagining discarded hypotheses.

Building upon the wisdom about the connection between electrical storms and forest mushroom abundance, researchers have advanced experiments to simulate the observed relationship between lightning strikes and the timing and yield of mushrooms. Numerous investigations link the pulsed electrical stimulation of inoculated oak logs and sawdust blocks with improved yields of shiitakes and other commercially important fungi.
In a study by scientists from Kyushu University and the University of New Zealand, a pulse power generator was wheeled along the ground, and electrodes from the machine made contact with the earth in a red pine plantation in Japan. Observers recorded Tricholoma matsutake fruited in their test areas but not in the controls, nor were naturally occurring fruitings reported anywhere else that year in the specific forest area where the study was performed. This “pine mushroom”, related to species T.magnivelare, T. murrillanium, and others found in similar forests across the Northern Hemisphere, is a valuable commodity, and its command of high prices has been linked to ecosystem damage by unscrupulous collectors.
If their results can be replicated, it may be possible to encourage the growth of mushrooms by applying current to the forest floor where wood is removed during fire prevention activities. As this could result in an abundant flush of ectomycorrhizal fungi, many of which are choice edibles, this could further be counted as a return on investment in maintaining the health and expanding the area of the existing stand of these fungal species’ tree companions. Harmonising what is removed with what is contributed to the common resources must always be central to any land stewardship plan.

Additionally, should versions of this technology be developed and shown to be effective, gardeners could apply it to stimulate their woodchip mulches by using the dosed current along paths between cultivated rows. Performing this activity at intentionally chosen intervals throughout the growing season, it may be possible to learn to steer ground-based mushroom fruiting in timing with other harvest windows, increasing efficiency by enabling a dualcollection strategy.
It takes diverse tactics to feed and provide efficacious medicines to populations made vulnerable by the effects of meteorological uncertainty. Whether living in high-density food deserts and located far from the source of their most basic nutritional requirements or dependent on predictable production costs and timely transport of those goods, everyone participating in this exchange is seeking greater security. Reinterpreting received wisdom to face new challenges head-on can generate creative strategies to link highyield regenerative farming and revisioned woodlot management goals with economic viability and regional resilience. 3
Xavi Kief is a writer, researcher, and lifelong learner with their hands in the dirt and their imagination traversing the universe. Seeking always to deepen and integrate their connection with the living planet and its diverse inhabitants, Xavi finds joy by infusing their practical and playful approach to cultivation with a healthy dose of science.They grow food and medicine for their family and community on their NorthEast Coast homestead.
it may be possible to encourage the growth of mushrooms by applying current to the forest floor where wood is removed during fire prevention activities
At its core is the addition of the new Samsung LM301H EVO 4000K diode. The EVO diode shifts the previous blue peak from 450 nm to 437 nm Plants grown under this plant-centric spectrum have bigger and thicker leaves and higher levels of nutrients.

I n c r e a s e d B l u e
New EVO 4000K diodes give plants a ‘photon pump’ resulting in up to 5% increased yields with no extra power usage. Deep blue targets peak chlorophyll & photosynthesis production for boosted vegetative growth & vigour

I n c r e a s e d R e d & Fa r - r e d



Higher Red and Far-red output for increased production in flowering plants. The right amount of Far-red light engages Emerson Effect, encourages early node staging and more flower sites.

I n c r e a s e d R e d , Fa r - r e d + U V UV & Red & Far-red offers maximum BPF (ePar). This encourages lateral branching, less stretching, enhanced lower size and improves essential oils, taste and aroma.

In this multi-part series, Alan Creedon writes about his decision to close his social media accounts and focus on creating real-life connections.The move hasn’t been easy, and the extent of his ‘addiction’ is becoming clearer; will it pay off? If you missed the first instalments of Alan’s series, find them in our digital magazines at
Iwant to see the world without the social media lens. I don’t want to think about how a moment in time will make a great post or wonder why nobody reacted later. I don’t like the general frustration and obsession of checking that comes with social media either. Still, I enjoy being plugged in, knowing what’s happening and feeling that connection with the broader world. So what is the point of disconnecting to such a degree? As I’m still in detox mode, I’m asking myself this question. Why leave it all at once?
When I take another look at that connection, I see the more subtle frustrations and irritations I held about the culture of ‘watching’ because that’s what we do on social media. A bit of watching, a bit of ‘liking’ and often not much more. It’s a non-committal relationship, which you don’t have to be there for, just watching from afar; this is my experience, and now I’ve left it.
The other day, I felt the withdrawal symptoms big time, and I then had a sudden urge to clean my bike – a thing I hadn’t done for a long time. The baby was asleep, so I took the bike apart outside the house and started cleaning. A neighbour was also outside painting, and we chatted while we worked. Then another neighbour came with a cup of tea and sat there for a chat. It was a lovely moment and became a social media therapy session with real people. Gill said she doesn’t use social media anymore and hates that she even ever checks her phone. Lorraine said that she needs it for work and is addicted (her word!) to Facebook marketplace, and that’s where she goes to find stuff for her house. Fair enough.
I could agree with both, and as the days continued, I noticed my checking behaviour all the more. I wasn’t counting, but I was checking my phone so regularly that I had no idea how often it happened. Now I didn’t have social media; I was checking Whatsapp, the weather app, and even my bank account more regularly than usual. The addiction was in the checking, seeing if something had changed or developed.
It came to a head last week when I released a newsletter (now my primary form of communication with the outside world). I found a subscription newsletter service that doesn’t gather and sell my data. So I released my newsletter, and it was gone. That
was it! Nothing to check. No stats and no way of knowing who’s opened it. At that moment, however, all was not okay. I felt strung out. I needed to see stats, check something, and know people care about what I share!

Feeling the withdrawal, I stamped around the house, looking for anything to help. Then I saw them. Two bright yellow Arthur Bell roses from our rose bush were in a small vase.
I was transfixed. I stood there and deeply inhaled their aroma. Then, losing myself in the folds of their petals, I was blown away by their beauty and the subtlety of what they offered me. It was a simple experience of appreciation and connection with the beauty of the natural world, replacing the tension of empty social media anxiety – the need for a quick fix. I knew I was onto something.
How often do you check your phone in a day? It’s time to count your checks. Find out what Alan will discover in our next edition of Garden Culture Magazine. 3
BIO Alan has worked in local food for over a decade and in that time has been involved in retail, wholesale and growing local produce. He is passionate about people working together and enjoys bringing his ideas into the world of veg. He lives in the West Yorkshire hills with his wife, daughter, son, dog and cat and loves walking in the hills, sleeping out in the woods, and having a dip in the river (but would sometimes prefer sleeping out in -3 than a dip in the river!). He will be publishing his first book this autumn. He is a mindfulness teacher, running regular courses and events as a nature connection guide. He likes to combine the philosophical with the practical.
I want to see the world without the social media lens
In the final part of this series, Cosmic Knot writes about his experience of a lifetime playing music with the oldest and most impressive trees in the world. We previously left him after an exhausting 240-foot climb up a giant sequoia in California. Will his efforts have paid off? We’re about to find out. If you missed the first two articles, find them in the digital magazine at GCMag.co

After the climb 200 feet into the sky, my body and nerves were pushed to their limits. I was shaking and couldn’t attempt to hook up the device to test it that evening. After the physical exhaustion and the distance I had traveled, I didn’t want to find out it didn’t work!
I came out before sunrise the following day and gave it a test run. It worked! I almost fell over with excitement. Here I was, getting a reading on a tree that is thousands of years old. Knowing this had never been done before, I didn’t increase the volume at the initial test. I wanted to wait for the students on their way to help plant so we could all hear it for the first time together.
The school kids came out to help with the reforestation effort, and I led the class. I taught them about the importance of mycorrhizae and its beneficial relationship with plants. Once the first tree was rooted in the earth, the students gathered around, and I plugged the device into the sequoia seedling. Initially, the tree was hesitant to make music. One of the students decided to try and touch the tree. Suddenly, it let out a loud sound and started to play, and the crowd laughed. I brought out my guitar and jammed with the newly planted musical sequoia.
Everyone was excited to see the tree’s musical reaction to the kids. The students loved the event and planted dozens of young sequoia trees from genetics gathered from the five largest trees in the world. We planted our way up the bluff and found ourselves back at the base of the Three Sisters tree.
I talked to the students about my 200-foot climb, showing them how we wired the tree for music. I plugged in the device and turned it on, hoping to get a charge. The signal worked! But again, the tree was hesitant to play. Once the students gathered closer, it seemed to spring to musical life.

After hearing the giant tree play music, the climbing crew told me to harness up so they could hoist me into the tree to play a duet. I strapped on my guitar, put on the climbing gear, looked at the World News reporter and joked about how my life keeps getting weirder by the second. It was hard enough climbing the tree with two free hands; now, I had to climb with my guitar, and I was still weak from the 200-foot climb the day before.
I began the climb and started troubleshooting how to play the guitar while hanging from a tree backwards. I played the guitar behind my back while standing on my head, but playing in the tree proved even more difficult. Eventually, I got the hang of it (no pun intended) and began playing with the giant tree for the first time.
I noticed a sense of wisdom in the giant sequoia’s playing ability. The tree seemed to instantly know where I was going musically, which impacted me significantly. This tree is thousands of years old, teaching me to be a better musician. I was interpreting my notes on a different level. I’ve had many strange experiences, but this was up there. I was humbled.
As it grew dark, I hooked up lights to the sounds of the tree so it could create a sound-controlled light display, cascading different hues of colour up each trunk like a celebration of lights after the day’s event. The next day, we packed up and moved on towards San Francisco.
After the climb 200 feet into the sky, my body and nerves were pushed to their limits
The West Coast is something out of a fairy tale. You can sense the vastness of the Pacific when you meet it, and it has much calmer energy than the Atlantic. Golden Gate is an excellent description as the late afternoon sun reflects on the moisture in the air, giving it that “golden” glow. It feels ancient and welcoming at the same time. Dolphins and seals jump in the waves as the sun sparkles off the ripples of the blue water.
After reaching the ocean and planting the last trees we brought to the Presidio in San Francisco, we went north along the coast towards the giant redwoods. After searching for a while, we came upon what is known as the Shrine Drive-Through Redwood Tree.

The West Coast is something out of a fairy tale. You can sense the vastness of the Pacific when you meet it, and it has much calmer energy than the Atlantic.
The giant drive-through tree is falling over and held up with cables to keep it from disintegrating. It is massive enough for cars to pass through the opening carved out of its centre. However, it has endured many blows from wind, lightning and fire. Seeing the tree in the shape that it was, I asked if we could clone the tree to help preserve it.
The owner graciously agreed to let us clone the tree, so we jammed with it and took cuttings. A group of tourists arrived while we were doing our work. Since the tree was still hooked up to play music, I thought it would be interesting to witness how it reacted as the car passed through it.
As the vehicle moved through the gaping hole in the trunk, the old giant started to make loud groan sounds and deep bass notes. It was music that didn’t correspond to anything we had heard before. You could tell that even though the tree wasn’t touched by the car passing through its centre, it could feel it. We felt remorse for the old tree.
After returning home and resting, we went to work with our friends, putting the cuttings we took from the DriveThrough tree into a rooting medium so they would grow and clone themselves. One of the friends helping that day was responsible for initially telling me about plant music. He also helped get us out west, which was a full-circle moment.

We noticed new growth on those cuttings from the DriveThrough tree on Christmas day. The cloning attempt was successful, and the trees seem to be living! I never thought I’d find myself trick or treating for cuttings of a giant redwood on Halloween. Then again, I never thought I’d jam with a giant sequoia, either. I learned a lot along the journey. The truth is, it continues even right now as you’re reading this. It’s only the beginning. The journey doesn’t end; it grows with all of us.
If you’re physically able, plant some trees. We’re all part of the story of Mother Earth, and she needs all the help she can get right now. 3
 BIO Tom Wall: Professional Musician, Writer and Gardening Consultant. Cosmic Knot/Therapeutic Horticulture Consultations. Growing up on a deer farm located on 79 acres of land along the banks of one of Lake Michigan’s tributaries, Tom grew a love for nature and all the beauties it could hold. Through that passion, Tom has channeled his influences into educating the community on sustainable agriculture, becoming an activist, writing for magazines and creating music tuned to nature in his band, Cosmic Knot.
BIO Tom Wall: Professional Musician, Writer and Gardening Consultant. Cosmic Knot/Therapeutic Horticulture Consultations. Growing up on a deer farm located on 79 acres of land along the banks of one of Lake Michigan’s tributaries, Tom grew a love for nature and all the beauties it could hold. Through that passion, Tom has channeled his influences into educating the community on sustainable agriculture, becoming an activist, writing for magazines and creating music tuned to nature in his band, Cosmic Knot.
If you’re physically able, plant some trees.
The students loved the event and planted dozens of young sequoia trees from genetics gathered from the five largest trees in the world













 BY MARCI BABINEAU
BY MARCI BABINEAU
Even if your garden is small, the amount of physical work it can take, especially in the spring or at harvest, can be astounding
 PHOTOS BY FIONA KEATS
PHOTOS BY FIONA KEATS
Even if your garden is small, the amount of physical work it can take, especially in the spring or at harvest, can be astounding. Bending, lifting, lifting and twisting, bending, lifting and twisting are all complex activities for the body that often don’t go down well after a long week at a desk. Or perhaps you are more like me, a landscaper or working on a farm, finishing plantings under the threat of weather, always moving, overworking, and pushing to finish during a short season. Ah, we can overwork! After a long day in the garden, my sister calls it “gettin’ a hurt on”.
So why don’t we naturally stretch and relax our bodies regularly as other animals do? If you are working with your body or just living in one, it makes sense to understand how it works.
It turns out that muscles are only designed to contract. Stretching is optional. Muscles are striated by fascia fibres that hold the body’s shape. If you liken muscle tissue to rubber, then fascia would be more like plastic. The way you hold your hips, shoulders and head, day in and day out, will be held firmly in place by the body’s fascia system. The facia also shortens and dries out as the muscles contract through use and dehydration. Over time, this is called old age.

Yoga postures are a simple way to systematise stretching and relaxation to help the body recover from all sorts of things, especially gettin’ a hurt on in the garden. It was developed by ancient humans, long before mechanisation and spandex, because they needed to use their bodies to do everything. Developments in yoga postures since its emergence from ancient India have brought us restorative yoga. This practice describes long-held, fully supported yoga postures that help the body open, release, rest, and relax. It is at the top of the list of things to look into during gardening season.
• Improved mindfulness, taking time to position your body, using legs to lift, etc.
• Moving with the breath, lifting during exhalation

• Training parts of the body to work independently as well as in unison
• Better balance and extension
• Improved endurance
• Awareness of when you are tired and valuation of resting
The body retains the yoga practice over time. It remembers how to stretch, lift, and pace. Practising conscious movements protect the body from accidents. Slowing down to take a breath before lifting increases strength.
It is helpful to think about the activities you will be doing in a work period and try to match your stretching to them. I can’t teach you yoga in 850 words, but you can complete the following moves in about 15 minutes, keeping you happier in the garden for longer. And hey, isn’t that what it’s all about?
Yoga postures are a simple way to systematise stretching and relaxation to help the body recover from all sorts of things, especially gettin’ a hurt on in the garden.










I can’t teach you yoga in 850 words, but you can complete the following moves in about 15 minutes, keeping you happier in the garden for longer. And hey, isn’t that what it’s all about?
Half standing forward bend. Begin by identifying something stable in your work zone about hip height. Place your hands there, shoulder width apart, then step your feet back, placing them hip distance apart. Your legs and torso should make a right angle, if possible. If you are using a wall, you can press your hands flat to stretch the wrists and fingers. Then, outer rotate the arms so the shoulders open around the neck. Your head stays at arm height. Use the thigh bones to draw the pelvis away from the shoulders. Breathe and relax where you can, keeping your legs and arms activated.

Leg stretches are done from the same place as the previous posture. Take one leg forward and the other back. The feet should be on the ground, hips squaring. The torso can be up with the chest lifted or lowered like in the previous posture. Hug the thigh bones toward each other. Repeat on the other side.
Forward bend with hands under feet is quite therapeutic for overworked hands. You want to step the big toes up toward the wrists. Keep the knees bent as much as needed.
Squatting strengthens the knees and opens your hips. Find something to hold onto to anchor you. Bend knees and lower hips. If your heels don’t reach the ground easily, adjust your distance from the anchor so they can. Bring your torso between your legs and relax your head toward the ground.
Tree pose for balance can be practised by putting your foot on the inside of your ankle, calf or upper inner thigh. Press the foot into the leg and the leg back into the foot. Ground the lower body as you lift and extend the arms overhead. Soften the eyes and focus on something.




Child pose takes your knees wide apart and your big toes together, laying your torso forward between bent knees and taking the head to the floor.
Rest with your legs on a chair (or hammock).
During all postures, breathe slowly through the nose. All postures can be held for 5-10 breaths. If you want to get more serious about yoga, find a small quiet class and bring a mat. In the meantime, keep stretching, breathing, and gardening! 3

BIO Marci Babineau grew up in gardens in California and Georgia. She currently gardens north of Montreal, Quebec, where she has nestled a food forest into a south facing hillside. Working in organic gardening and landscaping for 40 years, she has written about and taught a variety of gardening topics to young and old in Montreal and Cambridge, UK.

The average age of farmers is rising, and more people than ever are seeking therapeutic benefits and more sustainable living by gardening. Those with healthy and dexterous hands often take for granted that these complex and agile tools will be at-the-ready for any task set to them. Not just for menial work, hands are a critical tool in digital (it’s even in the name!) work and communication, whether typing on a keyboard, texting, gesturing, or using sign language. It only takes the puniest of papercuts, a pesky broken fingernail, or a strategically-placed blister to cause a surprising amount of frustration, irritation, and reduction in productivity.
Grip strength is often a key measure of health, and losing full use of a hand, even temporarily, can seriously impact mental health, morale, and efficiency. Generally, holding hands is an expression of affection and is associated with solidarity, as well as the release of oxytocin and accompanying feelings of calm and stress reduction.
It only takes the puniest of papercuts, a pesky broken fingernail, or a strategicallyplaced blister to cause a surprising amount of frustration, irritation, and reduction in productivity
We should all be driven to protect our hands to have a longer, more joyful life as growers. Therefore, it is essential to make good habits and the use of relatively inexpensive personal protective equipment an expected part of your cultivation culture.

Ensure you have the fit and construction of gloves and hand tools well-matched to the user and the job. Gloves that are too small or too big will hinder swift and comfortable action or cause injury. People tend to remove a glove (or any safety gear) if wearing it feels more like a hassle than a benefit. They will experience undue joint and soft tissue stress when their hands cannot correctly form an ergonomic grasp on objects.
Many beneficial plants produce resins, waxes, oils, or other secretions that the skin absorbs, causing a range of reactions in the body. Stinging nettles, for example, are helpful to incorporate into plant teas or ferments for feeding to other crops and in natural wellness applications for animals. They are also among the roughly 650 species of plants outfitted with ‘stinging hairs’, typically on their stems and leaves. While some folks find the sensation of being ‘stung’ by most
common varieties somewhat manageable, others report a burning feeling that can last for days. Previously thought to be the same mechanism of pain induced by the formic acid wrought by contact with fire ants, chemists now attribute the intense pins-andneedles sensation to a cocktail of histamine, acetylcholine, and serotonin unleashed upon the nervous system, with some plants producing extremely painful, even neuropathic results via physical contact.
Other phytochemicals are regularly encountered, especially at times of harvest and processing. These have less harm potential for mammals but can still accumulate or transfer to sensitive areas of the body, causing pain (e.g. capsaicin from hot peppers) or other undesired effects (e.g. phytocannabinoids in higher quantities than are usually experienced by the individual). These compounds are often effective as medicine in the appropriate dosage but can be stressful to the nervous system when overexposed.
Compostable or biodegradable nitrile gloves isolate bare skin from accumulating or transferring these compounds and provide additional assurance of cleanliness for end-users, especially where the product may be consumed raw.
Mixing substances for fertilisation, pest management, pH balancing, or cleaning can be an occasion for exposure to chemical burns (organic and inorganic), excessive drying, allergic response or other skin irritation. Check the manufacturer’s guidelines and follow their suggestions for what type of gloves or other cautions are recommended. Always perform these tasks within easy reach of a hose, sink or basin for emergency washing and clean-up to prevent cross-contamination.
Sun and windburn, dampness, and chill all affect the hands and can have long-term consequences for skin, joint, and nerve health. Wear neoprene or other flexible, easily-dried and cleaned gloves and avoid letting fingertips become numb from cold while working in wet conditions. Take breaks and stretch to ensure proper circulation. Look out for metallic, glass, or painted surfaces which may have become hot to the touch under the summer sun, and be sure to direct attention to sources of steam or other exhaust and pipes or vessels containing high-temperature fluids.
Hands and fingers are easily caught in hinges, doors, machinery, and between heavy objects and hard surfaces or structures. High-visibility tape or paint, combined with graphics-based signage, draws attention to areas where hands should never go, and marks recommended bracing points and the location of handles. While working with a partner to lift or carry, and whenever a door or shutter is being closed, or a wheel, pulley, or roller is being engaged, make confirmation of “Hands Clear” a regular habit.
It is important to note that, in some instances, wearing gloves can increase the risk of being caught in motor-driven moving parts. Having a well-labelled hook or bucket intentionally located close to the operator’s point of contact with the equipment (e.g. next to the key or electrical lock-out) acts as a reminder, as well as making it convenient to remove gloves (and, if applicable, rings or other jewellery) and put them back on as needed.
In even the most compact of grows, most cultivators will have some need to employ small tools with blades like scissors, shears, and knives. Ensure these are kept in good working order, free of slippery grease or dust, and regularly sharpened or replaced as needed. Any time the skin is broken, an infection may occur; make use of a properly-stocked first aid kit, keep a record of all incidents (including noting the object that ruptured the skin, whether it was cleaned or discarded,) and follow up promptly to make sure you do not require further medical attention.
Often overlooked, repetitive overly-tight gripping and improvised pinching or grasping of slippery objects like wet plant pots, hoses, container handles, and hand tools can result in cumulative strain on soft tissues in the fingers, hands, and wrists. Textured rubber on the palms of work gloves or affixed to the appropriate surfaces significantly reduces unneeded stress. Similarly, rubberised gloves may stop painful blisters formed by rubbing against wooden tool handles and defend against thorny bushes and splinters from wood, plastic, or metal under friction.
to harness and harmonise with hardworking hands include:
• Aloe vera for burns and joint pain
• Comfrey and chamomile for healing dry or chapped skin
• Most edible mushrooms, especially Reishi and Lion’s Mane, for nerve protection and antiinflammatory effects


Non-slip footwear, immediate attention to spills on slippery floors, and attempts to eliminate and call attention to tripping hazards also reduce the risk of hand harm when a falling person tries to catch themselves before hitting the ground.
Setting personal wellness as a primary goal while cultivating food and medicine for yourself and others means attending to the functional maintenance of your most critical tools: your mind and body. Strength and mobility exercises for the hands are easily incorporated into daily routines. Using herb-infused balms or creams and massaging into muscles and joints can also significantly improve and extend the experience of being “hands-on” in your growth.
Regularly remind yourself and others that preventing a small amount of time loss, product spoilage, or even damage to equipment is of little comfort when risky behaviours could result in loss of hand utility/mobility, amputation, or other permanent, life-altering injuries. 3
Setting personal wellness as a primary goal while cultivating food and medicine for yourself and others means attending to the functional maintenance of your most critical tools: your mind and bodyReishi
As wildfires burn worldwide, gardens thousands of miles away feel the effects. Smoke and ash can negatively impact our plants; here’s how to help them cope. Find this blog, more helpful gardening tips, and articles on current events that matter at GCMag.co.

No matter where you live, there is a good chance that you’ve experienced the effects of wildfire smoke. As the frequency and intensity of wildfires increase, so does the amount of smoke they generate. Carried by air currents, communities thousands of miles from the fire’s epicenter experience grey skies and ash falling like snow, coating everything with a fine powder, including the garden.
A study by the American Geophysical Union, published in the Journal of Biological Research, finds that smoke and ash are not all bad for plants. Researchers say that filtered sunlight caused by smoky skies makes plants more efficient.
The study looks at various plants and crops living under smoke-filled skies. The amount of sunlight available was lessened by only 4%.
The smoke has a scattering effect, allowing the sun’s energy and light to diffuse and penetrate more deeply into the plant canopies. As a result, the light reaches the entire plant, not just the topmost leaves, and helps plants photosynthesise better.

Falling ash covers the plant, smothering its ability to absorb light and grow. Wildfire ash results from burnt trees, which creates wood ash that many gardeners are already using to create nutrient-rich soil.
As long as the blanket of ash is not thick, it will help plants by providing nutrients such as potassium, phosphorous, calcium, and trace minerals.
Researchers at the University of California’s Berkeley Botanical Garden discovered that too much smoke and ash does indeed
smother the garden, obstructing the movement of carbon dioxide that the plant leaves need to “inhale” as part of photosynthesis.
A lack of CO2 for plants leads to water loss, creating the same impact as a severe drought. Thick smoke will also destroy chlorophyll, the pigment that makes plants green and enables nutrient absorption. When dense smoke blankets swaths of agricultural fields for weeks, crops grow smaller and ripen later.
However, even in this scenario, there is a silver lining. Plants will survive, albeit their natural cycles will become disrupted.
Perennials may be tricked into dormancy, thinking that winter has come. Others will stop growing to wait it out, and when the smoke clears, they will resume their natural cycles, blooming later and producing smaller yields.
Carried by air currents, communities thousands of miles from the fire’s epicenter experience grey skies and ash falling like snow, coating everything with a fine powder, including the garden.

If ash from forest fires becomes a problem in your region, wear your N95 pandemic mask in the garden to protect yourself from breathing in the smoke. Water and mist your plants to ensure the foliage isn’t caked with falling ash.
When it comes time to harvest the vegetables and fruit from the garden, clean them thoroughly with vinegar and water to wash away any residual ash. If your fruit and vegetables still smell like smoke even after multiple washes, it is advisable to discard them to the compost.
If the smoke is extremely thick, add some mulch to cover the roots of the plants. Burlap and canvas coverings can shield plants and shrubs from the ash. Moving pots indoors to a greenhouse or lighted shed will also provide peace of mind.
There is nothing good about a wildfire and its effects on those directly in its path or thousands of kilometres away. But knowing that there are things that we can do to mitigate the impact of the smoke and ash is at least a small positive ray of light. 3

A lack of CO 2 for plants leads to water loss, creating the same impact as a severe drought
We can’t say enough good things about mushrooms! These beauties are delicious and offer our bodies a wide range of nutritional health benefits. Including them regularly in your diet will help boost immunity, improve gut, heart, and brain health, and support weight loss efforts, among other things. So how do you get the most out of your mushroom harvest? Of course, eating them right away is an option, but keeping them long-term is too! This list of 5 Cool Ways To Preserve Mushrooms will set you on the right path and contains methods recommended by mycologists Britt A. Barnyard and Tavis Lynch in their incredible book, The Beginner’s Guide To Mushrooms: Everything You Need To Know, from Foraging to Cultivating.
Whether foraged from the wild or cultivated, many varieties of mushrooms will do well for about a week in the fridge. But don’t simply open the crisper and toss them in there; correctly storing mushrooms preserves their texture, flavour, and nutritional and medicinal properties. Wrap mushrooms carefully in paper, not plastic. You can also place a dry cotton cloth at the bottom of the vegetable crisper, put the mushrooms on top, and then cover them with another cotton cloth to prevent moulding. Never place wet mushrooms in the fridge; let them air dry on the counter before storing them. Field mushrooms, Black Trumpets, Blewits, Chanterelles, Morels, Hedgehogs, and Shiitakes are a few examples of mushrooms that are good fresh.


We’re often told that food is better fresh, but that’s not always the case with mushrooms! Drying is an excellent storage method for some varieties, including Black Trumpets, Boletes, Candy Caps, Hen of the Woods, Shiitakes, and Morels. Electric dehydrators are the best way to dry a harvest effectively. You can try to air-dry mushrooms using a fan, hanging them, or sun-drying them on screens outdoors. However, although the mushrooms may look and feel dry, there’s a chance they still contain moisture and will grow mouldy over time. When properly dried, mushrooms will keep for several years, ready to be eaten in risottos, stir-fries, soups, and stews. Regardless of the drying method, airflow is more critical than heat; dry mushrooms below 110°F (43°C). Store the dried product in airtight glass containers in a cool, dry place.


Not all mushroom varieties are well-suited for drying, but that doesn’t mean you can’t use the preservation technique and turn them into something else! While Oyster mushrooms, wine caps, and Chanterelles will dry nicely, the texture changes when rehydrated; nobody likes a mushroom that’s too soft or leathery. If you have an abundance of these mushrooms and can’t enjoy them fresh, you can always dry them and grind them into a powder. Mushroom powders are flavourful and can be used as a substitute for flour or cornstarch in sauces and gravies. Follow the same drying guidelines above, and then use a coffee grinder or pepper mill to pulverize the dried mushrooms into powder for all your culinary creations!
Corn smut and Shiitake mushrooms keep incredibly well in the freezer; other varieties will tolerate this storage method too. Worried about a soggy texture after thawing? The best way to maintain flavour and texture is to partially cook the mushrooms before freezing. Slice them first and blanch them in boiling water for a minute or lightly saute them. Then, throw them into an airtight freezer bag, and you’re done! When freezing large batches of mushrooms at once, it’s best to cook them and then lay them out on parchment paper-covered baking sheets, ensuring they’re not touching before placing them in the freezer overnight. Once frozen, put the mushrooms into a freezer bag. Thaw and warm them up when you’re ready to serve.
Does the mere idea of a canned mushroom turn your stomach? We don’t blame you! Unlike wild mushrooms, some cultivated varieties are well-suited for canning, like Hen of the Woods and Milk mushrooms. Experts recommend using a pressure canner or cooker. Wild varieties do well with pickling and are a tasty addition to your next charcuterie board. Pressure canners aren’t necessary for this process as the pickling brine’s acid, salt, and sugar will prevent bacteria from growing. In their book, Bunyard and Lynch suggest packing canning jars with sliced or whole mushrooms, depending on their size, and adding a clove of garlic. Mix the brine ingredients in a pot (usually cider vinegar, water, sugar, salt, and pickling spice) and bring to a boil. Pour the hot brine over the mushrooms and boil the jars in a canner for 20 minutes. Let the mushrooms sit for at least a week before opening to develop the best flavour! 3

We always recommend thorough research and help from an expert before foraging anything from the wild. When preserving mushrooms, it is essential to know what you are doing. Improper techniques and storage can lead to bacterial growth, making you sick. Bunyard and Lynch’s book offers plenty of guidance and is an excellent read for all mushroom lovers.






















